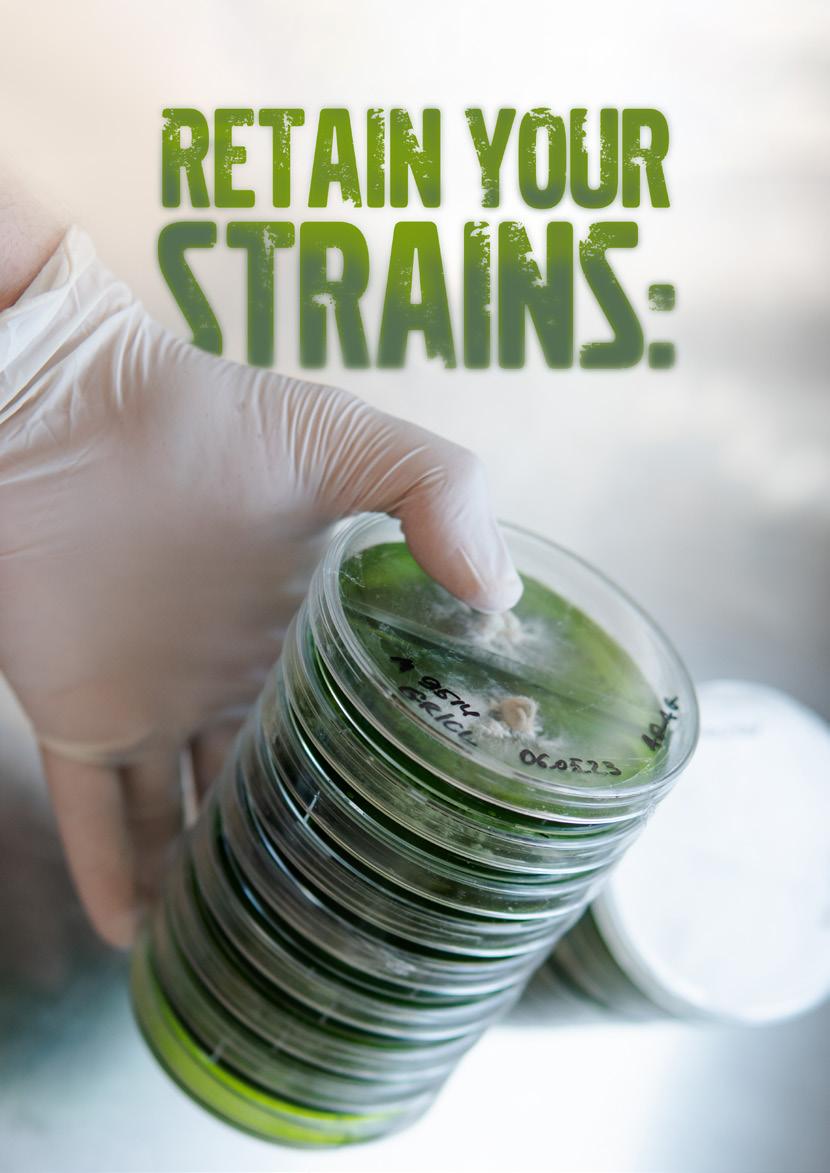

TRUSTED BY SERIOUS GROWERS SINCE 1994
One of the reasons we are so passionate about making this magazine is to share our love for sustainable growing methods that are good for plants, people, and the planet. The annual edition about organic and regenerative gardening is a big part of that mission. To be clear, I am not against mineral nutrients; I have been growing with them for over 20 years. However, I am against chemical pesticides and fungicides and Big Ag’s destruction of our earth’s soil. We are for building healthy soil and finding ways to grow your fruits, vegetables, mushrooms, herbal medicines, and foraging when possible.

Over the years, we have extensively covered organic and regenerative growing. If you search the words ‘organic’, ‘regenerative’, and ‘sustainable’ on our website (GCMag.co), hundreds of articles will appear. We are addicted to this subject.
This edition is chock full of great articles on various organic-themed subjects, including something from one of Canada’s greatest growers and our newest writer, Dustan McLean. His article, “Organoponics 2.0”, details his hybrid cultivation method that blends the best of organic and minerals. Our editor, Catherine Sherriffs, interviewed various regenerative growing experts for this edition and writes about building edible perennial gardens and the trendy topic of chaos gardening. You’ll also learn about biochar, foliar feeding, banker plants, living soil, and our universal hatred for aphids.
As we all know, there is no best way to grow, especially organically. Whether you use organic fertilisers in inert substrates, purchase premade soils, create your own super soils, or blend all the above, finding the suitable method for your plants and style is a matter of choice and experimentation.
We all want edition will help you on that journey.
Happy
Growing, Eric 3
SPECIAL THANKS TO:
Adam Clarke, Alan Creedon, Anne Gibson, Catherine Sherriffs, Claude Robert, Cosmic Knot, Dustan McLean, Everest Fernandez, Jennifer Cole, Lance Lambert, and Xavi Kief.
PRESIDENT
Eric Coulombe
eric@gardenculturemagazine.com +1-514-233-1539
EXECUTIVE EDITOR
Celia Sayers
celia@gardenculturemagazine.com +1-514-754-1539
EDITOR
Catherine Sherriffs cat@gardenculturemagazine.com
DESIGN
Job Hugenholtz job@gardenculturemagazine.com


DIGITAL & SOCIAL MARKETING social@gardenculturemagazine.com
ADVERTISING
ads@gardenculturemagazine.com
PUBLISHER
325 Media INC
44 Hyde Rd., Mille-Isles QC, Canada J0R 1A0 GardenCultureMagazine.com
ISSN 2562-3540 (Print)
ISSN 2562-3559 (Online)
Garden Culture is published six times a year, both in print and online.
@GardenCulture @GardenCulture @GardenCultureMagazine @Garden_Culture

You may not know Job Hugenholtz personally, but you definitely already know his work! That’s because he’s Garden Culture’s graphic designer, responsible for the gorgeous photos and artwork on our pages. He’s an essential and adored team member, and we’re so grateful to work alongside him every day. We asked him to share a few things about his creative process and life outside of Garden Culture.
Did you always want to be a graphic designer?
I’ve always loved drawing and visual arts, but growing up, I never seriously considered working as a graphic designer. I studied biology and almost worked in a lab. But when looking for work after my studies, I was lucky enough to have graphic design circle back to me. It’s a real privilege to enjoy doing your work, but even more importantly, to work with a great team of like-minded friends who all have their heart and soul in this GC project.
How do you create inspiration for the beautiful covers you design?
Garden Culture’s slogan is ‘The Art of Growing’; we always try to create something unique for each new cover. Every edition follows its own ‘gardening & growing’ theme in terms of content, so each issue has its character. Eric and Celia always give me the new edition’s artwork theme and necessary inspiration. Sometimes, you hit the nail on the head straight away, but other times, it’s a lengthy process of eliminating and fine-tuning. Eric and Celia always have fresh ideas and give great feedback. The final artwork requires their stamp of approval. It’s essential to have that external input, as sometimes, you can get a bit lost or ‘blinded’ when working for hours (or even days) on the same project.
Ask the Garden Culture team, and everyone has a favourite cover. Is there one that stands out as a testament to your creative genius?
No, not one in particular. Once a cover is finished and I see it in print, I feel accomplished for about 20 seconds before I see the flaws! LOL. But I’ve loved the creative process on all of them. The ‘Eschercover’ was a cool project, because I genuinely admire his creative genius.
What’s your favourite thing to do outside of work?
I spend time with my family and friends and throw myself off mountains on my enduro mountain bike (it’s my adrenaline-fuelled nature therapy).
You’ve travelled a lot with your family! Where in the world would you like to go next?
Ha, to be honest, I’ve not travelled nearly enough lately! I’ve still got a very long wish list: Azores, Marquesas/French Polynesia, New Zealand, South Africa, Belize/Costa Rica... don´t get me going, lol. One day! 3


Are you interested in writing for Garden Culture Magazine?
We’d love to hear from you! Send us an email introducing yourself with a sample of your work editor@gardenculturemagazine.com



BioGuano Nitrogen Formula features organic nitrogen derived from amino acids for ultimate dosing control that won’t burn your precious plants. BioGuano NF is lower in organic phosphorus (P) and calcium (Ca) than BioGuano+. BioGuano NF is supported by background nutrition, including potassium (K), magnesium (Mg), sulphur (S), cold water sea kelp and fulvic acid for superior nutrient assimilation. BioGuano NF is rich in organic carbon, improving nutrient retention and estabMycorrhiza and friendly bacteria. Give your cuttings, seedlings, and growing plants the organic love they deserve with BioGuano NF.
Check out BioGuano.com.au to learn more.



Athena Cleanse is a stabilised hypochlorous acid that dissolves mineral scale in pipes and irrigation lines by increasing ORP (OxygenReduction Potential) and flushing unwanted material. Athena uses specific methods for long-term stability in bottles and fertiliser batch tanks during manufacturing.
Athena Cleanse raises water’s ORP, increasing its ability to oxidise and reduce substances like mineral scale and organic matter.
Irrigation water contains minerals that can build up inside irrigation systems, causing friction, corrosion, and a general decline in function. Cleansing minimises required maintenance.
Biofilm and scale in irrigation lines can clog drippers and dehydrate plants. Regular use of Cleanse can avoid mineral scale inside irrigation lines, and it is safe to use with plants throughout the growing cycle.


Growing cannabis outdoors is easier than you might think! Here are some tips to help you get the most from your outdoor grow.


The sun is the best grow light on the market! Planting cannabis in full sun will yield healthy, vigorous plants. Select a spot on your property with at least six hours of sunlight daily, preferably more.
Leave the bottom open so the roots can grow directly into the ground
After selecting the spot for your garden, prepare the area. Measure the available area and divide that amongst the plants evenly. With big plants, it’s better to lean towards more room. Don’t cram too many plants into one section and limit airflow. Allow for approximately 144”x 144” per plant. Leave room for a walkway as well. Rows that are 36” wide will do fine.
Now, it’s time to build grow boxes. A grow box is a wooden square frame of boards filled with soil and amendments. You can also use chicken wire, wrap it into a circle, and line the inside with landscape fabric. Leave the bottom open so the roots can grow directly into the ground. Another option is to dig holes 24” deep and as wide as needed. However, in my experience, the raised beds work best.
Choosing the size of a container will determine the size of the plant. Growing large plants out of smaller containers is possible, but this will stress the crop. It’s all in the soil, and properly growing the plant’s roots is essential. Healthy roots equal healthy fruits.
When building the grow box, use untreated wood. To give the plants space, start with a minimum width of 48”× 48” and a depth of 24”. Plants generally tend to grow beyond the box’s perimeter, which can help you gauge the container size you need and adjust your row size accordingly.
If the plants outgrow the container, increase the frequency of watering. It’s not ideal, but it will get you through to harvest.
Once you have the containers, it’s time to fill them with dirt. Like container size, soil is essential to growing large plants outside. Make sure the soil drains properly, but not so much that you have to water more often. A good mix of peat, coco coir, rice hulls, and humus is an excellent start.
Many bagged mixes are available and ready to use, but I prefer building soil myself. My favourite blend includes peat, coco coir, rice hulls, hummus, earthworm castings, gypsum, and mycorrhizae. Afterward, add amendments. Since the containers have
open bottoms, it’s best to start there and condition the preexisting soil with amendments and mycorrhizae. Fill the container with the soil mix. At this point, adding a natural granular fertiliser product is recommended.
Adding extra gypsum to the soil will help with calcium and sulphur input. The correct balance leads to a healthy living ecosystem in the container. Adding red worms can help, but with an open bottom system, they will happily colonise it from the ground up.
The soil ingredients will be the biggest upfront investment. With proper care and maintenance, you can reuse the same soil for years (as long as there are no pest issues), but adding new organic inputs to revitalise the soil is crucial.
Select varieties that are acclimated to the local outdoor environment



Like container size, soil is essential to growing large plants outside




Once the soil is ready, it’s time to plant! Genetics are important, so get the plants or seeds from a trusted source. Select varieties that are acclimated to the local outdoor environment. Research reputable companies with a proven track record in your area.
Start the plants indoors in early spring before the outdoor growing season begins. Place the seedlings or clones under any daylight spectrum LED, CFL, or fluorescent lights. A bright, south-facing window will also work. When ready to go outside, it’s best to have plants fully rooted into at least 3-gallon pots. However, if the plants get too big indoors, it can take a while to acclimate to the outdoors.
Plant 30 to 40 days after the spring equinox. Any sooner, and they will go into preflower. Many growers wait two months after the equinox to be sure the weather and daylight are right for growing. You can put plants into the ground up to three months after the equinox and still achieve excellent results.
Once the plants are growing, keep them watered, but don’t let them get too wet. The first few weeks shouldn’t need much. After the plants establish, give them up to 10 gallons a day by midsummer, and give even more to very large plants.
Train the cannabis plants through a tomato cage for extra support. Once they outgrow the cage, add some trellis. The trellis can run either horizontally or vertically; gently pull the limbs outward and train them accordingly as they grow. Structurally, it’s better to grow the plants wider than taller for most varieties. Make sure the limbs are fully supported to avoid any breakage.

Many growers wait two months after the equinox to be sure the weather and daylight are right for growing
If the soil is nutrient-rich, you won’t need any liquid fertiliser, though it is a great way to boost plants. Brew a compost tea mix throughout the summer that changes with the season. When brewing teas, a handful of compost, humus, worm castings, or guano and letting it aerate for 24 hours can go a long way. Adding extra mycos, molasses, gypsum, and enzymes into the mix is also a good idea, but wait to add the myco until you’re ready to use it, or they might drown. The enzymes help break down the plant food in the soil.
As the garden grows, simple maintenance can help many problems. Canopy management increases airflow, reducing the potential for mould. Using natural beneficial foliar sprays like B.T. in veg can greatly reduce the issue of bugs munching on the plants and bringing in other problems. If the plants are healthy, they will also form a natural resistance to many common problems. It’s all about paying attention to their needs daily.
Once ready to harvest, you’ll need an appropriate space for drying and curing. For the best quality, dry the crops properly before trimming. For a step-by-step guide to curing cannabis, read “It’s Time For A Cure” in issue AUS31 of Garden Culture Magazine.
BIO Tom Wall: Professional Musician, Writer and Gardening Consultant. Cosmic Knot/Therapeutic Horticulture Consultations.
Growing up on a deer farm located on 79 acres of land along the banks of one of Lake Michigan’s tributaries, Tom grew a love for nature and all the beauties it could hold. Through that passion, Tom has channeled his influences into educating the community on sustainable agriculture, becoming an activist, writing for magazines and creating music tuned to nature in his band, Cosmic Knot.

Banker plants are a strategic tool used in integrated pest management (IPM) strategies. They serve as a habitat for beneficial insects, also known as biological control agents (BCAs), which help manage pests in agricultural settings. Here’s a breakdown of their functions and goals:
Banker plants are a strategic tool used in integrated pest management (IPM) strategies
banker plants can help reduce reliance on chemical pesticides or other traditional pest control methods
Supporting Beneficials Development: Banker plants provide a habitat and food source for beneficial insects, allowing them to settle and reproduce even before the targeted pest population establishes.
Increasing Allies Presence: By providing a constant food source, banker plants attract and maintain populations of beneficial insects, ensuring their presence in the crop environment.
Enhancing Effectiveness: Banker plants can increase the effectiveness of biological control by ensuring a consistent population of BCAs, which can lead to a higher success rate in pest management.
Risk Minimisation: Adopting a “standing army” approach with banker plants means that beneficial insects are already present when pests arrive, reducing the risk of pest outbreaks and minimising the need for reactive pest control measures.
Reducing Reliance on Traditional Products: By promoting natural enemies of pests, banker plants can help reduce reliance on chemical pesticides or other traditional pest control methods, thus promoting more sustainable agricultural practices.
Cost Reduction: Banker plants can reduce input costs associated with pest management term and environmentally
Holistic Approach: Using banker plants supports a holistic approach to pest management by integrating biological control methods with other IPM strat egies, such as habitat manipula tion and crop rotation.

Parasitic wasps effectively manage aphid infestations in various settings, including ornamental gardens, greenhouse crops, and bedding plant nurseries. Employing an Aphid Banker Plant System, these wasps thrive within a self-contained sustainable ecosystem. Here’s how it works:
The system is a miniature rearing hub for natural enemies, ensuring a constant supply of beneficial insects to combat pests. Specifically, a non-pest prey species, such as the cereal aphid (bird cherry-oat aphid, Rhopalosiphum padi ), is cultivated on grain plants like barley and wheat. These cereal aphids pose minimal threat to most greenhouse bedding plants, making them an ideal food source for parasitic wasps.
Aphidius colemani, a commonly utilised parasite, targets notorious aphid pests such as the green peach aphid (Myzus persicae) and cotton or melon aphid (Aphis gossypii ). When the population of cereal aphids reaches a threshold capable of sustaining the parasite population, Aphidius colemani is introduced onto the banker plant. Over time, the parasite population burgeons, dispersing into the crop to seek out and eradicate pest aphids.
Keep producing fresh banker plants throughout the growing to maintain efficacy. At the end of the it’s

Cabbage Whitefly (Aleyrodes proletella) and green peach aphid or the peach-potato aphid (Myzus persicae) on the underside of a leaf.

By incorporating pollen-based banker plant systems, growers enhance the effectiveness of natural pest management strategies and protect crops in a more sustainable and eco-friendly way
The advantages of this banker plant system are numerous: offers a cost-effective means of cultivating a steady supply aphid parasites, eliminating the need for recurrent purchas es throughout the season. Additionally, it reduces the lag between identifying an aphid infestation and procuring the necessary natural enemies from suppliers. Furthermore, it’s a straightforward process that requires minimal time effort.
This system can be adapted to accommodate other bene ficial organisms, such as Anystis baccarum, a versatile preda tory mite, and Aphidoletes aphidimyza, the aphid predatory midge. By harnessing the power of parasitic wasps and beneficial insects and mites, the Aphid Banker Plant System stands as a cornerstone in the arsenal of natural pest agement strategies, offering an eco-friendly and sustainable approach to aphid control.
In some banker plant setups, pollen is an alternative food source for predatory insects or mites. Specific plant varieties have been identified for their enhanced reproductive benefits for natural enemies. For instance, the minute pirate bug, Orius insidiosus, known for preying on western flower thrips and two-spotted spider mites, exhibits increased longevity and reproduction when provided with pollen from ornamental pepper (Capsicum annuum ‘Purple Flash’), common mullein ( Verbascum thapsus), or Lobularia maritima, commonly known as Alyssum.
These augmented reproductive benefits contrast those observed in predatory bugs simply purchased and released in standard biological control programmes. Unlike the Aphidius colemani bird-cherry oat aphid system, which can be initiated as needed, the minute pirate bug system requires a lead time of three to four weeks before the crop cycle begins. For banker plant density, use one pepper plant per 500 square feet of production space. You will only require one mullein plant per 1,000 square feet of growing space.


systems, can thrive on pollen plants designed to control pest mites, thrips, and other nuisances. Banker plants such as castor beans, corn, and ornamental peppers are commonly utilised in these systems. Because mites cannot fly, it’s crucial for banker plant foliage to overlap or touch crop foliage, facilitating their movement among infested crop plants.
Growers can establish colonies of predatory mites, ensuring that banker plants are populated with these beneficials a few days before or at the start of the crop cycle. This may involve infesting banker plants with mites weeks or even months before their placement in the greenhouse alongside crop plants. By incorporating pollen-based banker plant systems, growers enhance the effectiveness of natural pest management strategies and protect crops in a more sustainable and eco-friendly way.
In summary, banker plants play a crucial role in promoting biological control of pests by supporting beneficial insect populations, which ultimately helps to maintain crop health and reduce the need for chemical interventions. 3
Claude Robert is an IPM specialist & technical supervisor @ Anatis Bioprotection. He is an environmental activist passionate about biology and focuses on agronomy and entomology. Claude has worked in greenhouse research and outdoor small fruit production since 2004 and currently takes care of crops at Anatis Bioprotection with a team of passionate experts across Canada and the USA. He’s also doing a lot of research and development for Integrated Pest Management ( IPM).

Tired of all the negativity in the news? We feel you! Garden Culture Magazine wants to be a ray of cheerful sunshine; our new eco-optimism feature strives to educate and inform on meaningful environmental initiatives around the globe to get your positive endorphins going! Find plenty more feel-good content on our blog at GCMag.co
You can’t browse a gardening magazine and not appreciate fungi’s crucial role in soil biodiversity and plant health. Fungi represent a magnificent kingdom of organisms that take on various life forms; some are invisible to the naked eye, and others are fruiting bodies with sprawling underground systems. Fungi help fight climate change in many ways. They make nutrients available to plants, boost soil health, help sequester carbon, and break down common pollutants. We’re fans of the no-dig gardening method because it helps keep this precious soil life alive!
Considering fungi are incredible decomposers, putting them to work after death makes sense

According to the United Nations, the environmental impact of fungi extends beyond increasing soil biodiversity. They’ve been found to help decompose various pollutants, including plastic, pharmaceuticals, oil, and petroleum-based and personal care products. Studies have also found some species help with forest restoration projects and act as a natural pest control.

Did you know there’s a green burial industry? Standard burials are harsh on the environment due to the chemicals used to varnish coffins and during embalming. Considering fungi are incredible decomposers, putting them to work after death makes sense. Jae Rhim Lee was inspired and got the ball rolling, developing the Mushroom Death Suit for Coeio. It sounds creepy, but it’s an awesome idea. This garment is made with mushroom spores and other microorganisms that are said to help decompose a body and transfer nutrients to vegetation. At the very least, Lee’s invention got people thinking about ways to leave this Earth in an eco-friendly way.
According to the United Nations, the environmental impact of fungi extends beyond increasing soil biodiversity. They’ve been found to help decompose various pollutants, including plastic, pharmaceuticals, oil, and petroleum-based and personal care products.
We don’t suggest you walk around looking like Toad from the Mario franchise, but we do recommend you get in on fungi-forward fashion trends. Several companies use mycelium, the mushroom’s root structure, to replace plastic, synthetic, and animal-based products in shoes, clothing, bags, and more. The result is a product that looks and feels like leather but is biodegradable and takes less water and resources. Besides apparel, other mycelium-made products on the market include packaging and skincare products.


If you don’t regularly eat mushrooms, consider adding them to your dinner plate. Mushrooms are extremely nutritious, high in protein, and an excellent meat substitute for vegetarians, vegans, and flexitarians. Raising meat carries a massive carbon footprint, so finding alternatives and reducing our intake is crucial. Swapping meat for mushrooms is yet another way fungi help fight climate change! 3
Sources:
• Benefits of Fungi for the Environment and Humans (decadeonrestoration.org) rebrand.ly/5ffdc6
• High on Mushroom Fashion: How Fungi are Altering the World (sanvt.com) rebrand.ly/2szuimw
• How The Mushroom Death Suit Will Change The Way We Die (fellowsblog.ted.com) rebrand.ly/a0559a




Biochar is a carbon sponge that empowers healthy soil and is largely considered a climate change solution. Yet biochar’s magic remains elusive and misunderstood by many growers.
Astarte FarmDonna Balzer is a professional horticulturist who constantly researches what influences plant growth [1]. She learned about biochar during an online course and quickly tried it in her garden. Many gardeners lack experience with biochar, and there can be a lot of trial and error when working with it for the first time.
“I tried it as a growing media, and it was a disaster,” Balzer admits.
That’s because biochar is not a growing media. It works best as a soil conditioner when added to compost or organic fertiliser. It can work wonders in home gardens and large-scale agriculture alike, where, if used correctly, biochar can make a significant impact.
In 2021, agriculture in the United States emitted an estimated 671.5 million tons of CO2 equivalent into the atmosphere [2]. Almost 10% of all greenhouse gas emissions in Canada are linked to agriculture [3] .
Charlotte Levy is the managing science and innovation advisor at Carbon 180, a U.S. NGO advocating for eliminating carbon emissions. She says biochar is a powerful tool to help achieve global climate goals.
“Using biochar has the potential to remove 0.5 to 2 gigatons of CO2 equivalents per year globally, not just in the United States,” Levy explains. “On this scale, biochar can help to reduce legacy carbon emissions and aid countries in reaching their climate goals while also positively affecting the soil and creating a more reliable crop yield.”
Biochar already has a proven history of success. Thousands of years ago, Amazonian civilisations buried and burned food scraps and agricultural waste in covered pits or trenches. The carbon created stayed in the soil rather than released into the atmosphere. Archaeologists still find remnants of the dark earth “terra preta” created from this process [5]
In the 21st century, biochar is produced using more sophisticated methods. Organic materials such as wood, crop residues, or manure go into high-temperature and oxygen-deprived pyrolysis units (giant kilns). As the material heats, it puffs like popcorn into complex shapes called aromatic rings.
“A single piece of biochar the size of a grain of rice contains within its layers the surface area of two football fields,” says Dan Pratt of Astarte Farms, a no-till organic farm in Hadley, Maine [6] .

Biochar is not a growing media. It works best as a soil conditioner when added to compost or organic fertiliser
Pratt started using biochar to increase resilience in his soil systems and as a buffer against the climate crisis. As the planet heats, climatologists predict prolonged droughts and heavy rainfall events, which deprive the soil of nutrients. But not at Astarte Farm.
“We have endured several challenging seasons since we started working with biochar,” Pratt says. “The lattice structure of biochar enables [the soil] to absorb nutrients, water and a host of microbial life and then release them upon contact with plant roots. This buffering creates a more resilient soil.”
Despite these attributes, biochar remains elusive and expensive, costing between U.S. $600 to $1300 per ton. The largest biochar plant in North America in Port Cartier, Quebec, is set to open and, by 2026, could produce over 30,000 tons of biochar annually [7]. This initiative will make biochar more accessible and hopefully more affordable.
In the meantime, farmers like Pratt save money through on-farm production. Pratt can produce 15-20 pounds per firing using a double barrel retort. He is lucky to have untreated scrap wood on the farm. If the burned material has been treated with chemicals, harmful metals, such as copper or aluminium, will remain in the biochar and can be absorbed by plant roots.




Growing tomatoes and peppers in biochar-enriched soil reduced the need for
fertiliser by 50%
Biochar must be infused with life to be effective. Astarte Farm sprinkles the biochar with powdered mycorrhizae and mixes it by rolling it in bulk bags. This process activates the biochar but can be time-consuming. The good news is that biochar does not need to be reapplied to the soil like compost or other soil enhancers.
Meanwhile, Balzer adds biochar to the organic waste bin under her kitchen sink to inoculate it. She’s learned through experimentation the right amount to add to speed up the decomposition process.
“There needs to be more government support so that every single gardener doesn’t have to sort through all the methods and types of biochar available,” she says.
Her wish is coming true. If passed by Congress, the U.S. Biochar Research Network Act will provide research funding to study biochar’s effectiveness in crop production, carbon sequester and climate mitigation and provide practical information to farmers on biochar’s applications [8]
Scientists at Agriculture and Agri-Food Canada have already been researching biochar’s effectiveness [9]. Growing tomatoes and peppers in biochar-enriched soil reduced the need for fertiliser by 50%. These findings are significant because synthetic nitrogen-based fertilisers account for 2.1% of greenhouse emissions annually [10]
While biochar-enriched compost and potting soils are available, Levy of Carbon 180 says many growers remain leery.
“Gardeners and farmers would likely need incentives to implement biochar practices until a reliable market is created to bring down costs,” she surmises.
Convincing growers might be challenging. It’s always been the practical experience and results passed down through generations of gardeners and farmers that have informed and spurred new growing methods.
For example, Balzer believes that many people don’t grow broccoli because it is so hard to manage the pests. However, studies suggest that biochar promotes changes in soil microbiota, limiting pathogen mobility and insect pests [11]. For Balzer, the science is secondary to her pest-free delicious broccoli.
Back at Astarte Farm, biochar-enriched potting soil is used to grow transplants sold to the community each spring. Pratt says the farm’s loyal following of home gardeners swear by the plant starts. It must be something in the soil. 3
Sources
1. Helping Gardeners Grow - Donna Balzer (donnabalzer.com)
2. USDA ERS - Climate Change (rebrand.ly/4ce14b)
3. Greenhouse gas emissions and agriculture - agriculture.canada.ca (rebrand.ly/2ttrw47)
4. Carbon180 (carbon180.org)
5. Biochar, A Brief History - The Permaculture Research Institute (permaculturenews. org)
6. Astarte Farm | No-till Produce | Massachusetts (astartefarm.org)
7. Largest Biochar Production Plant in North America Contributes to Canadian Net-Zero Goals - Canada.ca
8. Grassley Introduces Bipartisan Biochar Research Network Act (senate.gov)
9. Biochar can turn plant waste into healthy soils and improve the environment - agriculture.canada.ca
10. Fertilisers cause more than 2% of global emissions (phys.org)
11. The Use of Biochar for Plant Pathogen Control | Phytopathology ® (apsnet.org)
BIO Jennifer Cole is a writer and garden enthusiast with a bachelor’s degree focused on history from Simon Fraser University, and a freelance writing career spanning two and half decades. Jennifer lives in Vancouver British Columbia. Her by-lines have regularly appeared in the opinion section of the Toronto Star and her portfolio includes articles in various newspapers, magazines, and websites across Canada. When not writing her own blog or visiting local garden centres, you can find her puttering, planting, and nourishing her own urban garden oasis.



any growers won’t reach for the spray bottle until they see a deficiency or pest issue and desire a “quick fix.” However, as Everest Fernandez explains, foliar feeding—spraying nutrients directly onto plants’ leaves—should arguably be part of your weekly garden schedule.
Imagine the leaf as a bustling hub. Light hits the leaf, allowing the tiny engines inside, known as chloroplasts, to convert water and carbon dioxide into glucose through photosynthesis. This glucose powers the plant and contributes to the compounds we aim to produce. Did you know a whopping 95% of a crop’s weight comes from photosynthesis?
Did you know a whopping 95% of a crop’s weight comes from photosynthesis?

So, how does foliar feeding help? Research in 1956 by Dr H. B. Tukey unveiled an exciting discovery. Using radioactively tagged nutrients, he found that plants absorbed nutrients not only through roots but also through their leaves, and incredibly, they do so 8 to 10 times more efficiently via their leaves. This suggests that direct application to the leaves can provide nutrients where needed, boosting photosynthesis and the plant’s overall metabolic rate.
However, there’s a challenge: the leaf’s waxy cuticle. It acts as a barrier. But science has a solution: special wetting agents that can penetrate this barrier without harming it, allowing nutrients to enter the leaf efficiently. This direct delivery to the leaf’s active parts results in a quick, beneficial response.
Once inside the leaf, nutrients face barriers like the cell wall and membrane. Most supplements can easily pass the porous cell wall. The cell membrane, however, is pickier. Some nutrients can move through effortlessly, while others need special channels or processes to get inside.
The good news? Plants have various methods to allow these molecules inside, such as facilitated and active transport.
Foliar feeding’s benefits go beyond just nutrient uptake. Certain supplements, like those that enhance photosynthesis, work best when applied directly to leaves. Evidence suggests that foliar-applied nutrients can be more efficiently absorbed than root-based nutrients. For instance, a study by the University of Florida found that foliar application of certain nutrients led to substantially larger citrus fruits than ground applications.
Chelated nutrients are wrapped in molecules to aid absorption and are particularly beneficial when applied as foliar sprays. They’re absorbed and distributed more evenly throughout the plant. Urea, another substance, when foliar applied, provides an efficient nitrogen source for plants, bypassing the challenges it faces when applied to soil.
Foliar feeding’s benefits go beyond just nutrient uptake

Foliar feeding offers a range of benefits, from increased yields, disease resistance, and improved drought tolerance to faster nutrient deficiency remedies and enhanced crop quality
Also, seaweed extracts, especially from types such phyllum nodosum, are increasingly recognised for their as foliar spray biostimulants. These solutions contain ble elements, like cytokinins, auxins, betaines, and essential minerals, all enhancing plant health, growth, and robustness. Plants, when faced with adversities like drought, salt or threats from pests and diseases, can find relief with application of these seaweed solutions. These sprays support plants by boosting their antioxidant defens es, regulating water balance, and fostering the pro duction of proteins and enzymes crucial under stress. Furthermore, these seaweed-infused sprays can to better nutrient absorption, invigorated root systems, and augmented crop yields.
Foliar feeding offers a range of benefits, from increased disease resistance, and improved drought tolerance er nutrient deficiency remedies and enhanced crop While the method’s efficiency varies, it can be up more effective than root application. Still, while able tool, foliar feeding shouldn’t replace a comprehensive root-fertility programme. Instead, it should be seen tastic supplement to optimise plant health and yield.






The word ‘perennial’ originated from the Latin ‘perennis’, meaning ‘throughout the years’ and gives us a clue about their long-term value
Ihave great respect for perennial plants. After working with many species over the years, I compare perennials to the foundations of a house. They underpin a garden’s structure and form the basis of design elements in resilient, welldesigned edible gardens. The word ‘perennial’ originated from the Latin ‘perennis’, meaning ‘throughout the years’ and gives us a clue about their long-term value.
Edible perennials are always my starting point when planning a garden from scratch or redesigning a space. They provide long-lasting value and enjoyment and are essential to a sustainable food garden.
1
Long-Lived Enduring Nutritious Yields. Perennial food crops have a great return on investment with a lifespan of at least two years but often decades, depending on the species. Plant once for long-term yields. For example, well-cared-for fruit and nut trees, like asparagus plants, can last decades. Passionfruit vines provide around five years of fruit. Berries re-shoot and fruit year after year, giving diverse nutrients for health. Some varieties, like mulberries, can’t be purchased in shops due to their short shelflife. However, they produce kilos of fruit in a home garden and are best eaten fresh off the tree.
2
Sustainable Food Supply. We live in uncertain times with disruptions to transport, fuel, and supermarket access during weather events. Skyrocketing food prices put pressure on the affordability of many fruits and vegetables. Edible perennial crops provide food sovereignty and security. Many perennial crops provide seeds to save and the ability to be self-reliant.
3
4
Time and Money Saving. Once perennials are planted and established, you can focus on short-lived annual crops.
Extensive Root Systems. Perennial fruit trees, vegetables and herbs tend to have deeper, widespread roots. This advantage enables many to develop mutually beneficial relationships with mycorrhizal fungi and access nutrients efficiently for healthy growth. These root systems stabilise and improve soil structure, helping to reduce compaction while improving aeration. The roots also minimise potential erosion, improve water holding capacity and expand the biodiversity of microorganism soil communities—an impressive contribution to soil health.
5
Dynamic Accumulators. Some of my favourite perennials draw up specific minerals deep in the soil. For example, I use Stinging Nettle for its medicinal properties and herbal tea and make a liquid fertiliser from the leaves. It is a good source of calcium and potassium. Likewise, comfrey leaves return calcium, potassium and magnesium to the soil and make a nutrient-rich mulch or liquid food for plants.
6
Low Maintenance. With some exceptions, most perennials require far less work than annuals. They can draw up minerals and moisture deep within the subsoil layers to survive longer without watering or feeding. Fruit trees and some edibles need pruning, but we don’t have to start from scratch each season.

Grapes are a perennial fruiting vine that live for years and are highly productive

Edible perennials are always my starting point when planning a garden from scratch or redesigning a space


Once their root systems are established, most perennial foods in my garden have been incredibly resilient
7
Easy to Propagate. Many perennials provide propagating material to expand your garden for free. For example, I take cuttings regularly from perennial basil, spinach and rosemary. Other edibles like capsicum, eggplant, and chillis give me free seeds. Clumping perennial herbs like chives can be divided as they touch the soil. This helps increase the number of plants I grow at no cost and with little effort.
8
Sizes to Suit all Gardens. Many perennial fruit and nut tree cultivars are available in full-size and compact dwarf varieties. This enables gardeners to choose suitable species according to their space requirements. Numerous fruit trees are grafted onto dwarf rootstock, ideal for pots or renters who need smaller or portable plant options.
Shade canopies. Fruit trees, vines and taller shrubs provide a vital shady microclimate role in the garden. The natural ‘umbrella’ a tree creates helps shade the soil and provide protection for sun-sensitive plants and a cool microclimate. Without these leafy shelters, birds, animals and plants wouldn’t survive in the garden for long. The branches and shade are places to retreat to in the heat, cold, storms or heavy rain.
10
Habitat and forage. Most of my fruit trees and many edible shrubs provide a protective haven for birds of all sizes to nest. The flowers offer a sweet nectar reward to pollinators, predatory insects and birds. These provide free pest management ecosystem services in the garden, reducing the need for chemical interventions. They contribute to a more biodiverse ecosystem in the garden.
Windbreaks. Many of the edible perennials I grow are chosen for their multi-functional roles. For example, Queensland arrowroot, galangal and feijoas help buffer the wind, reducing damage to other species. I often plant these in a guild to protect dwarf bananas or shelter shorter edibles.
12
11 9
Water efficient or drought hardy. Having been through several challenging droughts, I have had the opportunity to observe which edibles have been able to survive. Once their root systems are established, most perennial foods in my garden have been incredibly resilient. Some I rarely watered, and others didn’t need my help. Given the challenging climate conditions we are all experiencing, plants with low water needs are a significant advantage. Aloe vera, rosemary, garlic chives, eggplant and warragal greens are a few examples.
13
Store Soil Carbon. As many edible perennials lose leaves or are pruned, this organic material builds soil health by adding carbon as it decomposes. Because perennials live longer, their root systems effectively stockpile carbon, acting like a warehouse for organic matter.
14
Diverse colour and texture palettes. The diversity of colourful foliage, fruits and flowers, growth habits and textures provide infinite opportunities to create unique gardens reflecting our tastes. For example, I love blues and purples. So I grow perennial edibles like blueberries, passionfruit, eggplant, grapes and mulberries to add a splash of these colours throughout the garden. Their various leaf shapes and growing habits make them versatile and eye-catching as potager design elements.
Rosemary is easy to propagate by taking cuttings
Stinging nettle is a high value medicinal perennial that is used to make free liquid fertiliser for the garden

Because perennials live longer, their root systems effectively stockpile carbon, acting like a warehouse for organic matter
• They need a permanent location. Think carefully about where you plant perennials. Moving a perennial tree or plant is much more complicated once established, as its root system is generally deep or expansive. Perennials develop their resilience to climactic conditions over time. They can seek out moisture and nutrients at a greater distance than short-stay shallow-rooted annuals.
• They take time to establish. Whereas annuals sprint out the gate and are typically ready for harvest in a relatively short time, perennial edibles can sometimes take years before they are mature for harvest. Consider planting perennials as soon as possible, especially fruit trees.
• Consider mature size when planting. Allow enough space for perennial species to mature. Sometimes, I’ve underestimated just how fast some would grow and how much personal space they have needed! There’s nothing worse than overcrowding, which can contribute to poor air circulation, encourage diseases and make harvesting difficult. Research before planting and allow sufficient room with a buffer!
• Some perennials need regular pruning. While most perennial varieties are low maintenance, many fruit trees and vines need

ongoing attention to optimise their harvest and health. For example, citrus trees need shaping and decluttering. In some climates, grapes, passionfruit, and some berries will lose their leaves or die back, requiring a seasonal tidy-up.
• Choose perennial varieties of vegetables over annuals. Why plant annual leeks when a perennial variety will self-propagate into clumps for years? Over summer, growing salad greens in a warm or hot climate can be challenging. I swap to perennial options like sorrel, wild rocket, tree lettuce, dandelion, chicory, lemon balm and mint.
• Growing annuals as perennials. Depending on the climate, some edibles classed as annuals or biennials can grow for much longer. For example, in my subtropical climate, sweet basil has been growing consistently for over two years, as have my cherry tomatoes. I just never pulled them out! They like the position and soil and just keep growing. So, experiment and see what happens.
With so many benefits and uses, edible perennials are the obvious choice for enhancing our ability to live more sustainably with a resilient, productive garden for years to come. 3
Anne Gibson, The Micro Gardener, is an author, speaker and urban garden community educator on the Sunshine Coast, in Queensland, Australia. Anne is passionate about inspiring people to improve health and wellbeing, by growing nutrient-dense food gardens in creative containers and small spaces. Anne regularly presents workshops, speaks at sustainable living events, coaches private clients and teaches community education classes about organic gardening and ways to live sustainably. She has authored several eBooks and gardening guides. Anne shares organic gardening tips and tutorials to save time, money and energy on her popular website - TheMicroGardener.com
Watson pummelo tree with heavy crop of fruitCould hügelkultur gardening be the secret to maintaining a lush, self-watering container garden? Absolutely! Jennifer Cole tells us how to do it in this article from our blog. Find more sustainable gardening tips at GCMag.co.
As plants in containers grow, they use valuable nutrients in the soil that they cannot replenish naturally. As a result, they may need extra compost or fertiliser regularly. You should transplant ornamental shrubs or roses growing in containers every few years to refresh the soil and replace lost nutrients. But hügelkultur containers change all this, creating permanent, self-watering, nutrient-rich, long-term homes for all plant babies.
Generally, hügelkultur gardening systems create large raised or sunken garden beds by layering rotting wood and other organic materials.
By applying the same method on a smaller scale, hügelkultur gardens can be created using containers. Many needed ingredients are already in your recycling bin, kitchen scraps, yard, or along a favourite walking trail.
The recipe for assembling a hügelkultur container garden is as simple as layering and baking a lasagna. There are no set measurements; for example, extra cheese in a lasagna won’t harm the outcome, and adding more compost or fewer coffee grounds won’t ruin the hügelkultur container.

Hügelkultur gardens can be created using containers. Many needed ingredients are already in your recycling bin, kitchen scraps, yard, or along a favourite walking trail
• One well-draining medium to large container with a diameter of no less than 25cm and a depth of no less than 30cm is optimal. The bigger it is, the more room for layering.
• A bunch of twigs, small pieces of rotten logs, or branches.
• A medium-sized tub of yard waste, compost, or dried leaves.
• Green organics is anything you put into your kitchen waste or paper recycling bin, such as apple peelings, orange rind, eggshells, old tea bags, coffee grounds, paper towels, and even cardboard.
• One bag of ordinary topsoil.
Start by covering the bottom of the container 1/4 to 1/3 full of twigs or small branches, and pack it together as tightly as possible. You only add this layer once.
Continue by adding:
• 2-5 cm of yard waste.
• 2-5 cm of green waste (kitchen scraps). Mix in cardboard or paper towel with this layer, if desired.
• Another layer of yard waste.

As long as it’s well-draining, any container can have a long and useful life as a hügelkultur garden!

Repeat the process, depending on your container size, or until about 40% of it is filled. Smaller, shallower containers will require less layering than larger, deeper ones.
Use a watering can or hose to moisten the assembled layers. It will look like you’ve filled a perfectly good container with garbage or a compost pile that hasn’t matured. That’s great because that’s what you’re supposed to be doing: creating compost in a container!
The top organic layers act as a reacting agent, akin to baking soda in a recipe, to begin the decomposition process on the bottom wood layer.
Once you’ve added all the layers, cover with ordinary garden soil and water again. Remember, this is where plant roots will establish, so keep plenty of room for this top layer.
A hügelkultur container will grow anything from vegetables and perennials to large shrubs or annuals. As the material in the container breaks down, microbial life and essential nutrients, such as potassium, phosphorous and nitrogen, are released into the soil and absorbed by plant roots.
The energy released by the decomposing material at the beginning of the process will warm the container’s temperature. This heat will help newly planted perennials or shrubs stay cosy in winter and may even prevent the container from freezing solid.
Over time, as the organic material decomposes, add topsoil. But the decaying wood at the bottom will continue to act as a sponge, keeping roots nice and moist. As long as it’s well-draining, any container can have a long and useful life as a hügelkultur garden! 3

If there’s one crucial skill every grower needs to nail down right away, it’s propagation. Get your babies off to their best start in life; everything else tends to fall fairly easily into place. On the other hand, if you fail to nurture your seedlings and cuttings properly, the road to harvest can seem like a long, uphill struggle.
It doesn’t help that Instagram and [sickburp] TikTok are replete with sponsored ‘influencers’ confidently dishing out the same misinformed growing advice with ersatz authority—and propagation practices seem to be a favourite topic for misinformation. So— please—keep your mind open and accept the possibility that even stuff you’ve seen hundreds of growers doing online is...how shall we put it (?)…sub-optimal.
Let’s kick this enlightening process off with possibly the most cherished and commonplace cannabis propagation malpractice of all:
Ahhhh, you do this, don’t you? All your growmies do it; even that bearded, beret-wearing ‘licensed commercial cultivator’ who spams your LinkedIn feed does it, right? The rationale centres around a noble goal of mitigating the risk of mould issues inside the propagator by having fewer leaves in there, coupled with the practice of cramming 30 or 40 clones into a single fullsized propagator, of course. There’s also a vague notion that removing foliage will ‘force’ the stem cutting to focus on producing roots.
Here’s the thing: all you’ve done is unnecessarily wounded a fan leaf in several places and created a vector for fungal disease. Even if your scissors are sterilised, removing too many leaves and slicing off half the fan leaf blades can harm the cutting more than help. Leaves are vital for photosynthesis and help provide the energy needed for root development. So please stop doing this and start putting fewer cuttings in each propagator.
Still not convinced? Here’s some further reading: Mejía-Londoño, H.A., Barrera-Sánchez, C.F., & Córdoba-Gaona, O.J. (2023). Asexual propagation in female plants of cannabis. Revista Colombiana de Ciencias Hortícolas, 17(2), e16046.
The paper indicates that maintaining whole-leaf tips on cannabis cuttings benefits root formation and plant health. Specifically, it mentions that cuttings with three leaves and intact leaf tips have shown better root development and healthier plant outcomes in hydroponic and peat media. This finding challenges the common practice of trimming leaf tips during propagation, suggesting that intact leaves may provide better energy and hormonal balance for effective rooting and plant growth.
if you fail to nurture your seedlings and cuttings properly, the road to harvest can seem like a long, uphill struggle
Listen, I love a good 70/30 (coco/perlite) mix as much as the next person, but reserve this mixture for your vegetation and flowering rooms, not the propagation chamber. We’ve all read about ‘damping off’ and the dangers of overly wet, oxygen-depleted rooting environments; proper aeration and a balanced moisture level are crucial for healthy root development. However, the quicker wet-dry cycles associated with higher drainage soilless potting mixes can significantly increase the risk of salt buildup in the root zone—something to which cuttings and seedlings are very sensitive. Rockwool plugs or a pure coco mix in nursery pots are the way to go. Aim for 20 – 30% runoff each irrigation, and ensure you do not let your pots sit in that runoff; discard it, especially if you’re using a coco-coir-based potting mix.
Seedlings and cuttings don’t need strong nutrient solutions— quite the opposite. However, when mixing up very diluted feed solutions (0.4 – 0.6 mS or anything less than 300 PPM) using liquid or powder concentrates, the levels of trace elements like manganese, boron, and molybdenum can often end up being too low, even for very young plants, especially with reverse osmosis water. Specialist products such as Growth Technology’s “Formulex” or CANNA Start address this concern by providing elevatlevels of trace elements.

Alternatively, if you’re using a three-part nutrient system, you can use 1 part grow, 2 parts micro, 1 part bloom. However, be aware that there is often significant calcium in the micro part, so take it easy with any CalMag additions.


(noun)
Of enormous size or grotesquely large propor�ons.


Planting cuttings too deeply to promote root growth is misguided—likely an overhang from tomato propagation practices
It’s common to see growers germinating seeds or transplanting rooted cuttings directly into final-stage pots—especially those growing in living soil seeking to cultivate as ‘naturally’ as possible. Not only do those tiny plants look out of place in a 7-gallon or 10-gallon container, but irrigation and lighting also become immediate issues. It’s far more challenging to effectively illuminate a bunch of seedlings spread over a large area in large pots—and it’s much easier to overwater them, too. Patiently staging your transplants from plug to nursery pot to a quarter gallon or half a gallon before moving to a final container provides much better control over wetdry cycles, improves space management, and allows young plants to develop compact, vigorous root systems. Mycorrhizal products can arguably be used more efficiently and economically, too.
Sure, it’s exciting to see that first white root tip emerge from the bottom of your propagation cubes, but this isn’t your cue to start transplanting. The appearance of just one or two little roots should be just the beginning. Check your seedlings daily and focus on keeping them moist. When your propagation plugs are bursting with roots and starting to require more than one watering a day, now is the best time to transplant to a nursery pot or next-stage grow block.
If you do one thing every day, ensure it is just that—one thing. For instance, don’t transplant and top your plants on the same day. Transplant, wait a few days, then top. Avoid pruning your plants the
same day you move them into your flowering room. Efficiencies are important, especially as you scale up, but remember—prioritise the plants first and humans second.
LED propagation lights may offer features like high photon efficacy, full-spectrum output, and even dimming capabilities, but these advantages count for little if it’s too cold in your propagation tent. Growers switching from T5 fluorescents to LEDs should take special note. The most effective and efficient method to increase air temperatures in propagation tents is to use heat mats connected to a thermostat under the propagator tray. Set the thermostat’s temperature probe inside the propagator, ensuring it’s not touching the sides or bottom. Once plants are out of the propagator and transplanted into nursery pots, let them settle for a few days. If cool air temperatures persist, consider removing all the shelves from your propagation tent and installing a 315W CMH fixture.
Planting cuttings too deeply to promote root growth is misguided—likely an overhang from tomato propagation practices. Burying the stem too much can lead to stem rot and fungal infections—plant cuttings at a depth that supports them upright without burying a significant portion of the stem. 3



Living soil is an organic gardening method that uses a nutrient-rich potting mix teeming with beneficial microbes to grow plants instead of mineral fertilisers. It aims to create a sustainable mini-ecosystem in the soil, modelled after the natural processes found in nature. Everest Fernandez discusses how growers can transition from soilless potting mixes to organic living soil.
Living soil is all about nurturing soil life. The central goal is establishing a nutritionally balanced soil mix teeming with beneficial bacteria, fungi, protozoa and more. These microbes form symbiotic relationships with plant roots, helping them absorb nutrients effectively; they break down organic matter and mineralise nutrients into plant-available forms, recycling nutrition.
Living soil can be reused from one crop to the next—nothing to compost and nothing for the landfill. Of course, for optimal results over several crops, the nutrition and overall health of the soil must be monitored and maintained.
Some living soil practitioners prefer to amend their soils upfront—think “living super soil”—and irrigate with water only through to harvest. Other growers prefer a lighter starting mix to retain the control of choosing when to supplement with targeted and tailored top-dressed nutrition. In either case, it’s essential to understand the soil’s dynamic ecosystem and its effect on plant health. A thriving microbial life is a cornerstone of a robust living soil system.
Some early hype about living soil could have scared some stores from stocking it! After all, what store owner in their right mind would sell their customers a bag of “magic soil” that lasted forever and freed them from ever buying a bottle of mineral nutrients again? The reality is that living soil growers require a regular influx of sundries such as water purification products, powdered organic inputs, high-quality compost, bio-stimulants, mycorrhizae, and more. Some stores are further along the curve than others when it comes to catering to living soil growers.
Living soil blenders, like mineral nutrient formulators, pay close attention to the ratios of cations (ammonium, calcium, magnesium, potassium and sodium) with the appropriate amount of total nitrogen for the intended use (higher N for water only and lower for a ‘light mix’). Over time, these minerals will become depleted in the soil. Increasingly, indoor gardening stores offer a range of specialist organic inputs that can help restore specific minerals or mineral groups to more optimal levels. See the table: Common Amendments Used to Rejuvenate Living Soils.
Establishing the proper nutritional balance in the soil is just the beginning. Growers also need to ensure that microbial life is present in all its forms so that these nutrients are sufficiently available to plants. If microbial life is lacking, growers must use additional inoculants and compost extracts. Products used to boost beneficial biology in soil include beneficial bacteria powders and liquids (Bacillus methylotrophicus, Bacillus subtilis, and Bacillus licheniformis), fungi (Trichoderma), enzymes, amino acids, kelp powder and extracts, hydrolysed fish proteins, and insect frass. Different microbes play specialised roles. Bacteria decompose organic materials into simpler compounds, mycorrhizal fungi draw in water and nutrients via their threadlike hyphae, while protozoa graze on bacteria to mineralise nutrients. This intricate web of microorganisms creates a sustainable and efficient nutrient cycle within the soil.

Living soil can be reused from one crop to the next— nothing to compost and nothing for the landfill
Most living soil beginners overwater their plants. It’s easiest to commit this mistake when transplanting into final-stage pots.
Living soil requires minimal initial watering. Many living soil growers use “the 5 - 10% rule” to help them. Early on, they only water 5% of the pot volume. So, for a 20-gallon pot, the recommendation of 5% would be to water just one gallon—water only around the plant at first. After establishment, growers can progress to keeping the entire surface moist (still using the 5% rule). When plants are firmly established, growers can increase watering to 10% to mitigate the risk of the lower layers of soil drying out.
Remember, don’t treat living soil like coco coir and water until you get 30% run-off! Creating leachate will completely over-saturate your soil and rinse away some of the valuable nutrition it holds.
Large fabric pots are the most convenient for many indoor growers, providing excellent aeration to the roots. Be sure to get the size right. Think about the volume of fabric pot you might use for a large plant in a soilless mix and then double it for living soil. Generally, growers should allocate 60 to 120 gallons of living soil mix per 4’ x 4’ of canopy. So, if you’re growing four plants in a 4’ x 4’, that’s 15 to 30 gallons per plant as a minimum.
US-based living soil growers, in particular, favour a larger volume of soil. Thirty gallons would be considered a minimum rather than an upper limit! Larger volume containers facilitate a more extensive root system and better moisture retention.

The less soil you use, the harder it will be to keep your plants happy without resorting to liquid feeds. However, one issue that growers should be aware of is the tendency of living soil near the sides of fabric pots to dry out more, making life more difficult for beneficial biology at these physical fringes. Growers must pay close attention to even watering and consider insulating the sides of pots to maintain consistent soil moisture and temperature.
If you want to raise your growing game a few notches, consider constructing or purchasing a living soil bed to accommodate multiple plants. Gareth Griffin, the new World Record Holder for heaviest onion, grew his 19-pound (nearly 9 kg) beast in a living soil bed. This incredible feat was achieved using only organic cultivation techniques, causing many growers worldwide to start paying attention.

Some growers create different layers within the beds, the most common practice being a bottom layer of fast-draining, high-porosity material, like perlite.



• Contains hypochlorous acid - a natural descaler
• Increases Oxidation-Reduction Potential (ORP)
• Prevents drippers and emitters from clogging
• Made from fully soluble potassium silicate
• Used to increase fertilizer solution pH
• More cost-effective than competitors


Establishing the proper nutritional balance in the soil is just the beginning
Sacramento-based living soil enthusiasts, Grassroots, offer specially adapted fabric soil beds that mitigate moisture loss through the sides. They recently collaborated with BuildASoil in the US and Ecothrive in the UK to offer living soil beds to a wider market, including an automated living soil system using Autopot’s Tray2Grow wicking system. Beds offer the advantage of fostering a ‘community root system,’ which can lead to significantly improved plant health and yield. When growing in beds, growers can go to town with allocated soil volume, and the plants benefit from an interconnected root system rather than being isolated in their container.
Beds simplify rejuvenating and maintaining the soil, making it easier to add amendments and manage the soil ecosystem. Some growers create different layers within the beds, the most common practice being a bottom layer of fast-draining, high-porosity material, like perlite.
It’s a lot easier to reuse living soil when using beds. Commercial living soil growers typically veg their plants in two or three-gallon fabric pots with the bottoms cut out. At transplant time, the plant is not removed from the pot but lifted and re-positioned directly on the living soil bed. This means you lose potential head height, but vertical space is less commonly an issue for commercial growers. When transplanted, the lower roots enjoy access to the living soil below. At harvest time, growers can take the super low-labour option and cut plants at their base, leaving the remaining roots to be reintegrated into the living soil—typically via the addition of enzyme products that aid in the breakdown of the roots. However, more living soil growers are adopting the practice of cutting out root balls and replacing them with fresh living soil mix to mitigate the risk of propagating root-borne diseases between crops.
Living soils are typically based around sphagnum peat moss or coco coir—both serve as a moisture reservoir for the soil and are critical for fast-growing, demanding plants. Compost and organic fertilisers like alfalfa, bone meal, kelp meal, feather meal and rock minerals provide balanced, slow-release nutrition for microbes. Worm castings inoculate beneficial species, while bio-stimulants like insect frass can introduce microbial diversity.
Irrigating with water will suffice for most of the plant lifecycle, but some hungrier species will likely require supplementation. Be sure to use dechlorinated water so the soil microbiology can thrive. Organic liquid feeds can be used sparingly if needed, but scratching in some top dressing with organic powder amendments mixed with high-quality compost is the best way to ensure longer-term nutrition. Indoor gardening stores looking to serve living soil growers should be mindful of stocking various quality organic inputs to help cultivators replenish their soils.
Don’t forget to test your soil regularly—at least at the end of a growing cycle so you know which amendments you should be reaching for. Logan Laboratories in Ohio offers specialist soil analysis services that provide the necessary detail to amend your living soil efficiently and effectively. Commercial living soil growers will give their soil analysis to a specialist soil consultant, who advises on which amendments to add. While trace minerals are typically the first to dip to sub-optimal levels, nitrogen is the hardest (and most important) to maintain due to its volatility and high demand, followed by Ca, Mg, P and K.




Worm castings inoculate beneficial species, while bio-stimulants like insect frass can introduce microbial diversity.
No discussion about living soil would be complete without a mention of crop quality. Maybe you’re happy with the results from soilless, Grow A & B, Bloom A & B, and liquid Hocus-Pocus—but it’s the crop quality produced by living soil gardens that’s really turning heads. Denser flowers, vivid colours, more sophisticated terpene profiles, higher potency, and longer shelf-life are just a few of the talking points. As such, the best living soil-grown produce is often in high demand. 3
Alfalfa Meal
Basalt Rock Dust
Bat Guano
Blood Meal
Bone Meal
Calcium Carbonate
Composted Manure
Feather Meal
Fish Bone Meal
Gypsum
Green Manure/Cover Crops
Insect Frass
Karanja Meal
Magnesium Sulfate (Epsom)
Seaweed/Kelp
Soy Bean Meal
Thermo Compost
Worm Castings
Wollastonite (calcium silicate)
N, P, K, Calcium, and other micronutrients
Micronutrients, particularly silica
High in N, P, and micronutrients
High N, some micronutrients
P, Calcium
Calcium, helps in pH adjustment
N, P, K, and micronutrients
High in N

P, Calcium
Calcium, Sulphur
Varies with crop type, generally N, P, K
N, P, K, and chitin
N, P, K (similar to Neem meal)
Magnesium, Sulphur
P, K, micronutrients, and growth hormones
N, P, K, and other micronutrients
Balanced N, P, K, and micronutrients
N, P, K and micronutrients
Calcium, Silica, and other trace minerals





Combine Optic Foliar TRANSPORT with any foliar solution to allow you to spray in full sunlight with no damage or burning, residuals to wash off or the need to spray the undersides of the leaves. Transport is the only spreader to maximize absorption to the plants Mesophyll Layer. LIGHTS ON

TRANSPORT provides superior spreading and wetting capabilities that allow you to spray in full sunlight with no damage or burning.

Check out our complete product line:










Modern gardeners can help protect and encourage local bird species in many ways, from putting up feeders to planting fruit bushes and nectar-rich blooms. Another fun way to help struggling bird populations is to grow your own bird seed! Coneflowers and sunflowers are a beautiful addition to any garden, and songbirds like sparrows, chickadees, Tufted Titmice, Northern Cardinals, and American Goldfinches adore them. Selecting the right flower varieties can save you from buying seeds while keeping the birds flocking to your feeder or garden. We gathered some inspiration from Jen McGuinness, author of the newly released Bird-Friendly Gardening: Guidance and Projects for Supporting Birds in your Landscape
McGuinness says birds love the purple and pink coneflower blooms, and they’re less work for you because there’s no harvesting required. You can purchase this hardy perennial from a nursery and plant it in the garden after the last risk of frost. Coneflowers can also be started from seed, but sow them in the fall; the seeds need cold moist stratification for proper germination. Enjoy these beautiful blooms in the garden all summer, and leave them standing after they fade so the seeds can ripen. When the colder months arrive, birds like finches will come in droves to enjoy a much-needed snack.
There are many gorgeous sunflower varieties, but when growing bird food, skip any type labelled ‘pollenless’ because these will not produce seeds. Sunflowers are easy to grow, making them an excellent project for beginner gardeners or children. Sow the seeds directly in the ground or raised bed in a sunny spot after the last frost date in your region; protect them from chipmunks and other hungry critters with netting or lightweight garden cloth. As the flowers grow and the seeds begin to ripen, many birds will come to harvest their food directly from the flower. Or, save the seeds for the winter months by removing the ageing flower heads and covering them with a brown paper bag or cheesecloth. Doing so will allow the plant to breathe and the seeds to ripen. Hang them upside down in a warm, dry place with good ventilation. After about three weeks, seeds will drop out of the sunflower heads as they dry.
Coneflowers and sunflowers are a beautiful addition to any garden, and songbirds adore them.
Birds Attracted to Coneflowers and Sunflowers:
• Mockingbirds & Thrashers
• Chickadees & Titmice
• Thrushes
• Woodpeckers
• Blackbirds & Orioles
• Finches
• Crows, Magpies, & Jays
• Cardinals, Grosbeaks, & Buntings
• Waxwings
• New World Sparrows
• Kinglets
• Wrens
• Nuthatches
• Creepers
• Vireos
For expert advice on gardening for birds, pick up a copy of Bird-Friendly Gardening: Guidance and Projects for Supporting Birds in your Landscape by Jen McGuinness. 3

This is the sixth and final instalment of Alan Creedon’s documentation of his journey to leave the world of social media behind. Read all about his decision and the challenges and triumphs in his previous articles in our digital magazines at GCMag.co.
This past week was a much better one. There were more blackcurrants to ‘top and tail’, and I spent the weekend in the woods taking people on a Nature connection experience. I invited each person to leave their phone in their car, which they duly did, and I was pleased about that. One person didn’t even know how to turn theirs off, as they had never done it before!


It was fascinating to watch the hesitation of the attendees as we started the retreat, wanting to take a photo of the scene or watching their habits of going for the phone to check in with the outside world

Ironically, I was the only one with access to a phone over the weekend; I was the emergency contact and the ‘responsible one’. It was fascinating to watch the hesitation of the attendees as we started the retreat, wanting to take a photo of the scene or watching their habits of going for the phone to check in with the outside world. But as it happened, they were already there.
They quickly adapted, though. I didn’t hear anybody talking about their phone on the second day. Part of the retreat was for them to sit in one spot for six hours, having prepared for the sit spot through various relaxation and opening techniques. Seeing how they embraced the space was incredible, and all returned to childlike ways of experiencing the natural world. They played in the river, saw magical, inexplicable things happen, and reflected on their life situation in a way they would otherwise not. It does not take long.


Seeing how dependent we’ve become on phones to run our lives, I feel sad. They have become a necessary part of us, something we regularly touch, check, caress, and trust to be our reliable connection to the wider world. Yet behind every phone interaction is an unknown number of people working hard to sell you useless things and use your information to make you feel more connected to your phone experience. They build your trust so they can exploit it, creating a facade of reliability and dependability when it’s mainly about exploitation. Of course, the phone itself is a fantastic piece of technology. However, at this stage in the evolution of this technology, it is highly exploitative and untrustworthy. Something about that feels wrong.
We trust our phone experience but can’t trust our next-door neighbour; we feel disconnected from a world we’re destroying yet will happily allow tailored news and opportunities to flood our virtual timeline. It’s time to rethink our interactions. The connected mobile phone provides a personal experience that’s ‘ours’, i.e., nobody can interfere
with us and our ‘phone time’, which belongs to us. But that’s not true. Our natural desire to feel connected personally has been removed from the beauty of emotional commitment. It is also being observed by hundreds of organisations, selling our information and investing time and money to keep us on our phones. The dopamine hit replaces the ‘uncomfortable’ feeling of actual connection, which doesn’t have that instant pleasurable feeling but is about the ebb and flow of relationships over time. We need other people and the natural world to help us see ourselves as we are messy and wondrous beings. The phone will always show us our aspirational selves, the narcissus in the mirror, the outward, impersonal, and shallow.
If we can be aware of this, we can break the chains of tech dependency and help the people around us do the same. Let’s trust that we are infinite beings who impose limitations on ourselves. Interacting with our environment and the people around us will bring us more than any phone experience ever could. So leave your phone at home and walk, knowing that the experience matters, not the second-hand experience the ‘connected’ world will sell us. Please do it now!
Will you walk on the wild side and ditch social media like Alan Creedon? Whatever your decision, we encourage you to make an effort to connect with people and our planet without the help of your phone! 3
Alan has worked in local food for over a decade and in that time has been involved in retail, wholesale and growing local produce. He is passionate about people working together and enjoys bringing his ideas into the world of veg. He lives in the West Yorkshire hills with his wife, daughter, son, dog and cat and loves walking in the hills, sleeping out in the woods, and having a dip in the river (but would sometimes prefer sleeping out in -3 than a dip in the river!). He will be publishing his first book this autumn. He is a mindfulness teacher, running regular courses and events as a nature connection guide. He likes to combine the philosophical with the practical.
Mushroom growing starts with curiosity and can quickly become a passion. Like in any other cultivation niche, once you enjoy success, you’ll find endless directions to take your new skills and knowledge. Should you try a similar variety or challenge yourself with more complex projects? Is it personally rewarding to falter in an ambitious leap into new territory and learn from the experience? Or is it better to fine-tune your techniques and improve the quality and yield of a familiar crop?
Mushroom growing starts with curiosity and can quickly become a passion
Until recently, obtaining viable and trustworthy samples of new mushroom starting materials was challenging. Seekers of new and interesting mushroom experiences had to go foraging IRL. They took to the forest, the field, or restaurants with knowledgeable chefs, speciality grocery stores, and traditional medicine practitioners.
While these options are still accessible today, habitat destruction and increased demand drive economic incentives and the everyday person’s rationale for growing their food and medicine.
It’s good that beginners can find more mushroom-specific suppliers for the basic equipment and materials for home growing and that do-it-yourself, small-budget, and grassroots knowledge-sharing are built into the mycophile milieu.
Like heirloom or heritage plants, unique fungi strains can become a dependable standby or signature of your seasonal offerings
Direct-to-consumer sales of spores and culture syringes remain largely a cottage industry, with regional specialists offering cloned local varieties alongside commercially proven strains.
If you have the financial means, you can access any mushroom culture you wish via these online vendors. Aside from concerns about the legality of certain fungi, shipping logistics (e.g. distance and in-transit environmental factors) are the main threats to the viability of purchased (or traded) specimens for starting your own grow.
You’re likely to find there are particular fungal species or subtypes that you want to keep on hand. It may not always be the “right time” to grow a certain mushroom due to environmental conditions beyond your control, or your dedicated cultivation space is in rotation, keeping some species on the bench while others are in play.
Whether or not to keep a strain archive, if there is nothing extraordinary about genetics, is a question of resources and mindset. Like gardeners, mushroom growers come from all walks of life. Financial circumstances can change without warning, and infrastructural failures, weather anomalies, or other disruptions to a production schedule can threaten entire seasons’ worth of effort.
Cultivators need only look to the recent history of plant agriculture to imagine how access to favourites can become threatened by ecosystemic biodiversity loss, DNA patenting and engineering, changes to laws and their enforcement, and global supply chain disruptions. Food security researchers agree that seed saving at the local level should be supported “actively and at scale”, informing our approach to preserving beneficial strains of fungi.
Like heirloom or heritage plants, unique fungi strains can become a dependable standby or signature of your seasonal offerings. It could be the match is physiological, the partnership especially beneficial to your health or suited to your taste. Perhaps it’s practical, and the working relationship is smooth and fruitful. Though eternity may be elusive, regenerative techniques may work to keep that special companion in your life for more than a season or two.
So, how can a grower hold onto their mushroom genetics? Is it worth the effort?
You’ll only know if a strain is exceptional once you’ve grown it out. By this time, unless you’ve kept some of the original stock in good health, it will be more difficult to copy it.
The first time you do a liquid medium inoculation, hold at least half of the commercially-made syringe in reserve by keeping it in a sealed container in a fridge. Undisturbed in this cooler temperature range, cultures have been reported to survive for many months, even years. Consider this your “vault” and hope you don’t need to use it.
Before you move on to grain inoculation, use your first jar of living culture to make at least one more. Fill the syringe again, sterilise the needle, label it and put it in the vault. You can expand a liquid culture repeatedly if it remains uncontaminated.
Propagation of mushrooms is similar to rooting cuttings from wellknown donor plants; vigorously growing cultures are more apt to thrive, overcome adversity, and produce abundant yields.

















Save your faves, bond with others through trades, and be generous with your knowledge!

In properly-made jars with filtered airflow (so the broth can be aerated and carbon dioxide made by the mycelium can escape) and self-sealing injection ports, many common mushroom species will rest comfortably at room temperature in a dark cupboard for several months.
Before sealing and sterilising jars of your chosen liquid medium, include a glass marble. This is critical to maintaining the usability of your culture; “habit stack” agitating the culture with another regular routine, like making your first cup of coffee in the morning. A minute of swirling the marble around the bottom of the jar keeps the broth full of fresh air and breaks up the mycelium, encouraging it to keep growing and preventing the formation of a static, floating layer (it’ll resemble a kombucha SCOBY or even start trying to fruit, and make it more difficult to suck up into another syringe for propagation).
Multiply both the initial culture and the first copy you made at the same time. Experimentation with substrate recipes is one way to vary the pace and reveal opportunities for value-adding (or costsaving) by using what’s on hand. Examples include birch or maple sap in liquid cultures or bulk seed intended for feed or cover crops in grain cultures.
In bigger root cellars, research suggests mycelium living on sorghum grain can be held in reserve between 5-8°C for more than one year, free from contamination and without any growth and morphological changes.
Similar to a passionate sourdough baker always trying to use up their discard and give it away to anyone who’ll provide a good home, it’s inevitable that you will have more copies than you can rationally manage. Thankfully, redundancy is a great way to release that cherished cultivar into the community and invite the possibility of a future reunion.
Mushroom beds, with substrates replenished regularly with adequate nutrition, are a “living library”. Similarly, inoculated stumps and logs preserve a strain specimen for as long as it can feast on the wood without being overtaken by competitors. Either type of permacultural installation can serve as a genetic reserve, and exposure to adversity may even push a common strain to adapt for survival in local conditions.
Using robust fruiting bodies as source material for cloning is one way to (re)capture and perpetuate a favourite strain. Taking and archiving spore prints is a lower-barrier but riskier way to save such genetics.

Perhaps it won’t be long before the mainstreaming of home mushroom cultivation inspires the proliferation of genetics banks and community libraries. In parallel with seed-saving initiatives, conserving a diversity of spores and live cultures is a noble endeavour. Preserving locally adapted mushroom genetics of all types promotes and supports wellness practices at the individual and community levels. It’s in the public interest to integrate fungi into existing food and medicine sovereignty initiatives and to continue spreading education and access.
Save your faves, bond with others through trades, and be generous with your knowledge! 3
Do:
• Collaborate with others in your network when ordering new strains to take advantage of better pricing and make local trading more interesting and resilient.
• Stock plenty of extra empty syringes if you have the means. Make putting backup syringes in the vault part of your production schedule.
• Label every container with a minimum of the fungal species name, origin, and date.
• Keep meticulous records of your activities, from strain acquisition through inoculation, expansion, and harvest.
• Choose a regular interval to refresh your inventory of cultures in storage, and mark it on the calendar or set an alert.
• Assume you can purchase the same genetics again, even if the vendor is still in business.
• Become overly emotionally invested. A lost genetic may be grieved, but you’ll find another to take its place. Get by with the help of your friends!
• Deuss, A., C. Gaspar and M. Bruins (2021), “The impact of the COVID-19 pandemic on global and Asian seed supply chains”, OECD Food, Agriculture and Fisheries Papers, No. 168, OECD Publishing, Paris, doi.org/10.1787/ e7650fde-en.
• Sperling, L. Seed security response during COVID-19: building on evidence and orienting to the future. Food Sec. 12, 885–889 (2020). doi.org/10.1007/ s12571-020-01068-1
• Veena SS, MeeraP 2010 – A simple method for culture conservation of some commercial mushrooms. Mycosphere 1(3), 191–194. rebrand.ly/d20350
 BY ADAM CLARKE
BY ADAM CLARKE




After discovering another aphid infestation in his greenhouse, Adam Clarke lets his emotions run wild.
Another season of growing, another aphid problem. But wait a minute; it’s the end of January, and aphids aren’t supposed to be an issue. However, my greenhouse is 80°F+, and this is another epic outbreak!
I suspect that in my 20’x40’ greenhouse, we have more than 50,000 aphids, and that’s just what I can see. Two weeks earlier, there wasn’t an aphid in sight. Go away for a bit, and bam! The aphid army is back
Aphids are the bane of my existence, and I am determined to kill them once and for all
Our greenhouse runs seven days a week, 365 days per year. We heat it with a wood fire in the winter and mist it throughout the summer for cooling. We can create a fantastic wintertime environment, as it’s much easier to control the humidity. I didn’t consider that not having a freeze/thaw cycle meant we didn’t have a chance to kill all of the aphids from the previous season. The aphids and I have gone to war more than I can count. These little buggers seem to bounce back again and again. We have used organic fungicide-like products, insecticidal soap, and an army of predator bugs. I have too many aphids to tackle now; they’re all over my plants. My quasi-indoor/outdoor greenhouse doesn’t allow for a tight enough environment to keep aphids out and predators in.
We have started a rigorous procedure of inspecting all plants and spraying them with BioCeres from “Anatis.” We have tried this in the past without enormous success. However, we didn’t follow the directions well the first time. We will give it a go every five to seven days for four weeks and see what happens. We’ll use this product in conjunction with castile soap. We aim to manage all of our pest problems without using insecticides in our soil. We do not grow organic but do our best to keep it that way. On top of this, I just ordered my largest army yet: 5,000 ladybugs. This is overkill, but 1,000 wasn’t enough last time! My war on aphids will continue, and I will up date you on the progress after we have either lost the battle or figured out how to win!


Aphids seem so harmless when you see them in your garden, but really, they are sucking the life out of your plants. The ants bring them in and farm the little green bastards, no different than someone who farms sheep. The ants protect the aphids and help them by carrying them around and hiding them from the cold in winter. Aphids reproduce in a few different means that all seem overly complicated. All I need to know is that you can go from almost none to an unlimited amount two weeks later.
I thought I had learned this lesson after the last two aphid infestations. However, it appears I did not. I will never run my greenhouse again without a constant supply of good bugs. Bugs are the way to go if you do not want to use chemicals.
Aphids are the bane of my existence, and I am determined to kill them once and for all. ‘Operation Extermination’ continues!
F*ck Aphids. 3
Bio Adam has provided planning and design services for cannabis and hemp cultivation and processing facilities over the last seven years with Stra tus. His projects involve outdoor cultivation, indoor cultivation, cessing, extraction, storage, bottling and packaging, and more. Living on loves all plants, including flowers, passionate about hemp and of the benefits it offers to


Another season of growing, another aphid problem




If you ask Christina Chung, the future of growing is multi-layered, filling all available garden space with mostly edible perennial plants
Look around a typical suburban neighbourhood, and you’ll often see homes sitting on plots with grass, a specimen tree, and perhaps some shrubs or a foundation hedge. In the backyard or on the patio, some raised beds, flower pots, or a vegetable patch with tidy rows of crops growing. There’s nothing wrong with these traditional landscapes, but they can be better. If you ask Christina Chung, the future of growing is multi-layered, filling all available garden space with mostly edible perennial plants. The result is a garden bursting with biodiversity, increased soil health, and much less maintenance than what has become the standard.
Don’t get too overwhelmed just yet. Creating a layered edible garden doesn’t mean removing everything you already have growing; Chung recommends building on what is there, adding different layers while mimicking nature as closely as possible.
“Mixing and matching is a fun way to approach it,” she says. “This is not a cookie-cutter approach. It’s your garden and your experience with your garden. What you can give to it is unique.”
Like following permaculture practices to build a food forest, this gardening style typically includes plants of different statures from eight layers
Chung is a passionate gardener and educator (@fluent.garden) living in Vancouver, Canada. She is also the author of The Layered Edible Garden: A Beginner’s Guide to Creating a Productive Food Garden Layer by Layer. The book is about leaving the long, straight, boring rows of pest and disease-prone vegetables in the past and looking to the future: an interplanted polyculture where layers of edible plants out-compete weeds, share resources, and grow beautifully together while helping people become more self-sufficient.
Taking a ‘plant this, not that’ approach, Chung emphasises the importance of replacing traditional landscape plants with edible perennials. For example, boxwoods serve a purpose in a formal landscape but not a layered edible garden.
“An edible shrub that looks somewhat similar is Chilean Guava,” Chung explains. “I talk about this a lot in the book; it’s one of my favourites in the garden. It’s a small shrub. It’s evergreen, with dark green leaves similar to boxwoods [...] If you have a row or even a cluster of them, it’s quite impactful. They flower white and produce red berries towards the end of the growing season. You get almost four seasons of interest, depending on where you are, and you get to eat the fruit.”
Keeping it simple is crucial; nothing in the layered edible garden has to be exotic





Like following permaculture practices to build a food forest, this gardening style typically includes plants of different statures from eight layers:
• Trees
• Sub-canopy trees
• Shrubs
• Vines
• Herbaceous perennials
• Annuals
• Ground covers
• Edible roots
Perennial plants are investment pieces that cost more at the outset and take time to establish. But once they do, Chung says gardeners are rewarded with lush, eco-friendly, and productive landscapes that don’t require much labour. Perennial plants return each year with prolific harvests. Intensely planting them prevents weeds from growing, requires less watering, and boosts soil health by keeping the ground covered and undisturbed, unlike pulling out and planting annual crops. Plus, propagating new plants from established perennials is easy, ensuring you have plenty of plants and perhaps enough to share with friends and family. More layers!
Chung is particularly proud of an apple bed she has created in her home garden, which includes a dwarf apple tree and, below that, shrubs with colourful flowers to add visual interest and soften the look. Under the shrubs, she has flowers. She’s always experimenting with different edible treasures and was particularly happy with how her Swiss chard looked when incorporated into the bed one year. Her ground cover of choice is fast-spreading and deer-resistant creeping thyme.
Taking a ‘plant this, not that’ approach, Chung emphasises the importance of replacing traditional landscape plants with edible perennials
“Thyme is one of the groundcovers that I rely heavily on because they flower in the spring through the summer and sometimes into fall,” she says. “They’re a reliable ground cover with the right soil conditions.”
Strawberries are also an excellent choice to cover the ground. Chung encourages gardeners to research various plants and experiment from season to season, growing what they love to eat and what makes sense in their regions. Keeping it simple is crucial; nothing in the layered edible garden has to be exotic. Her book includes several examples of plants under each of the eight categories.
You don’t need much property to try layered edible gardening, and you also don’t need to include plants from all eight layers. This gardening method is scalable to many different spaces and skill levels, meaning it’s always in reach.
“If you are just starting and you don’t know if this is a style that you can try, start small,” she says. “It could be a container and doesn’t have to include all eight layers. Some of the most successful and productive plantings only have three, four, or five elements.”
For example, in her book, Chung suggests a five-layered edible garden including a hops vine as a climber, roses as shrubs, hostas and sage in the perennial layer, kale, chard, and violas in the annual layer, and violets as ground cover.

Gardening is an experience; it’s not a rush to accomplish something to prove to someone
A simple container garden on a patio might include a fig tree, herbs, lettuce, pole beans, and more. Live in a city with a small balcony? You can still enjoy a layered edible container garden.
“It checks a bunch of boxes,” she says. “It gives you privacy. You get this vertical lush wall that gives you food. And you get this shaded layer underneath that keeps your cooler-loving crops happy.”
Chung says you can’t go wrong when designing your layered garden space, which relieves some of the stress of jumping into a new growing venture. But she warns there are a few golden rules or guidelines that essentially lean on the good old-fashioned gardening basics.
“If you have a plant that requires sun to thrive, look for a sunny spot,” she explains. “Otherwise, the plant may be unable to do well and produce the food you want. Ultimately, in an edible garden, you want those elements to harvest at some point.”


Chung understands how easy it is to become overwhelmed by embarking on a new growing journey, so she suggests starting small, researching, and getting excited about creating a layered garden space. Her book, The Layered Edible Garden, is an excellent read and an inspiring place to start. Ultimately, Chung wants gardeners to remember that growing food is not a competition and that each garden is unique.
“I am gardening in a way, at a scale, in a style, that makes sense for me and my family,” she explains. “I think that’s really the big takeaway. Gardening is an experience; it’s not a rush to accomplish something to prove to someone.”
So, what can you do with your garden space? Remember, the future of growing food is multi-layered, and there’s no better time to start than the present. 3
The Layered Edible Garden: A Beginner’s Guide to Creating a Productive Food Garden Layer by Layer is available online at most major bookstores. Follow Christina Chung: @fluent.garden
BIO Catherine is a Canadian award-winning journalist who worked as a reporter and news anchor in Montreal’s radio and television scene for 10 years. A graduate of Concordia University, she left the hustle and bustle of the business after starting a family. Now, she’s the editor and a writer for Garden Culture Magazine while also enjoying being a mom to her three young kids. Her interests include great food, gardening, fitness, animals, and anything outdoors.



 BY CATHERINE SHERRIFFS
BY CATHERINE SHERRIFFS



FRelinquish all control and see what sprouts
Chaos is meant to be disruptive. It’s meant to make you uncomfortable, and that’s how we learn best
or many years, gardeners have known the rules: start seeds indoors and nurture them until they’re ready to be planted outside. Don’t forget to harden them off! And for the love of God, space them properly in tidy rows or forget any harvests. Now, imagine not doing any of that, grabbing a packet of seeds and casting them
haphazardly throughout the garden space. Relinquish all control and see what sprouts. Is your chest feeling tight?
Welcome to Chaos Gardening.
“Chaos is meant to be disruptive. It’s meant to make you uncomfortable, and that’s how we learn best,” says award-winning author and gardener Stephanie Rose. “I don’t feel that gardening needs to be so planned and so maintained.”
Rose should know. She’s an herbalist, permaculturist, and the author of several books, including two of my personal favourites, Garden Alchemy and The Regenerative Garden. Both books guide gardeners through working with nature and restoring the planet while growing productive, sustainable home garden spaces that don’t require much work. Rose’s love for regenerative gardening jumps off her pages, and after our recent video chat, I can confirm her passion is contagious. Rose has a way of making you want to do better, and it helps that she offers concrete and easy ways to achieve that goal in her books. During our talk, she tells me about her recent lawn adventures at her new home in Vancouver, BC, where she’s defying all of the traditional rules of growing grass. Rose didn’t prepare the land or buy truckloads of new soil. Instead, she pulled up the existing pieces of grass, planted 1,500 bulbs, covered them back up, and tossed a wildflower turf alternative over some compost mixed with sand.
“It is complete chaos,” she admits. “And I did it two months before the seed packets said I could do this.”
She’s at nature’s mercy and is perfectly fine with that. Rose is expecting some losses. Whatever grows is meant to be there; anything that doesn’t would never have survived, anyway. She’s open to learning from the plants and creating her space based on what they tell her.
“If we have too much ego going into chaos gardening, then that’s where we will not succeed,” she says. “If we go in with humility and an open mind to learn, then we will be able to grow as gardeners as our gardens grow with us.”
Chaos gardening is all the rage, trending on TikTok and Instagram. Videos of ‘chaos carrots’ popping up in random garden spots are getting over a million views. The new generation of gardeners is keen on ditching the traditional growing rules and the constant work typically associated with tending plants. Rose believes today’s gardeners understand they must correct many mistakes from the past, and that’s why the topic is trending. They want to toss carrot seeds and wildflower seed bombs into bare garden spaces and see what happens. They don’t want structured gardens with tall plants in the back, shorter ones in the front, and dyed mulch between them. They’re ready to move away from the perfectly manicured lawns that are weed-free yet dying of thirst.
Chaos gardening is all the rage, trending on TikTok and Instagram. Videos of ‘chaos carrots’ popping up in random garden spots are getting over a million views









“The generation coming up sees this as lawful evil because it’s not supportive of our environment,” Rose says. “It is so much labour, and they’re thinking about a whole generation of people who didn’t garden because they could see how much work it was.”
Chaos gardening is the definition of low-maintenance. Rose recommends researching the plants that do well in your region and buying seeds that speak to you. Cast the seeds widely and often, forgetting about spacing completely. Water and see what grows.
“You’re going to have far lower germination rates than you would if you followed [directions] and had done it in a greenhouse and set all the plants out,” she says. “However, seeds are inexpensive. Your time is valuable. Your energy is valuable, so you’re doing a bit of a trade-off here.”
As the plants grow, you will notice some varieties thriving more than others. When they establish, Rose recommends digging up anything that doesn’t fit the space properly and placing it elsewhere in the garden. It’s as simple as that, and that is regenerative gardening. Or, should we say, chaos gardening?
“Well, it’s just a different name for the same thing, right?” Rose explains. “But I love where this is coming from because this is a whole new generation embracing the idea of chaos as something positive.”
Russell Taylor, vice president of Live Earth Products and international Certified Crop Advisor, turned to chaos gardening as an act of desperation. Gather

It’s chaotic, regenerative, and wonderful
“I had an area in front of my house and planted some boxwoods, but they died. And then I planted a small pink Japonise willow, and that died,” he recalls. “I just couldn’t get anything to grow. I had to have something green. I cleaned out the seed bin, threw it out in front of the house, and what grew is what grew.”
Today, he has a beautiful self-propagating area of zinnias and salvia growing outside his front door. That’s what nature intended for his space, and Taylor has learned to listen and embrace the chaos. He also experiments with vegetable crops and fresh herbs, randomly sprinkling radish, spinach, arugula, kale, and cabbage seeds throughout his raised beds. Strawberries roam around the base of his asparagus plants. He planted dill ten years ago and hasn’t replanted it since; the herb just won’t quit! Taylor suggests watching these more invasive crops to give others a fighting chance, thinning as needed.
“Carrots, for example, whether it’s chaos-seeded or planned, if they’re too crowded, they don’t get the proper nutrients,” he says. “So, you thin them. One of the keys is to say, ‘We sowed some chaos. Now let’s get some organisation, so these things aren’t competing too much.’”
Taylor is a soil guy, so he stresses the importance of building living earth to allow the plants to reach their full potential. He also recommends understanding seed habits, especially if you live in a small space where porch and patio varieties are better than anything indeterminate.
Rose sees no reason why people living in small spaces shouldn’t scatter seeds in a pot and watch them grow. She also encourages indoor gardeners to get in on the chaos on their windowsills or wall planters. Culinary herbs are an excellent start, but we can take things further by regrowing food from kitchen scraps in water. These crops may not be as productive as the ones growing outdoors, but something is always better than nothing.
“Great mistakes are how we learn,” she says. “The biggest thing to watch out for [with chaos gardening] is not being open to what the lessons are.”

Luckily, nature’s lessons are everywhere in our gardens, meadows, and forests. Crowded plants die back in natural settings, allowing others to intermingle and thrive. Dense woodland plantings provide living mulch, preventing soil erosion and water evaporation. They also offer habitat to beneficial insects and other wildlife. It’s chaotic, regenerative, and wonderful.
So, don’t be afraid. Gather seeds you love and scatter them throughout the garden like nobody’s watching. Don’t worry about spacing, density, losses, or any other great mistakes you might make. See what grows, be excited about nature’s surprises, and learn from them. Most of all, let loose and embrace the chaos. 3

Stay up-to-date with our Garden Culture Blog
Stay up-to-date with our Garden Culture Blog



Our blog is where we bring you more than we can cover in our print issues; timely news, growing tips, and great ideas. Hundreds of growing articles are waiting for you. @gardenculturemagazine




It can be rough out there for plants. Even in controlled environments, growers constantly evaluate the pros and cons of letting a given individual reach the end of its natural life in situ
For tidiness and IPM, folks intervene on ‘weeds’ and other ‘volunteers.’ Breeders “rogue” atypical, underperforming, and otherwise undesirable plants from their seed-making populations to ensure consistency and make improvements. “Extras” are thinned to create space and focus resources. Gardens are inherited from people with entirely different aesthetic or horticultural priorities.
The climate also plays a part in forcing decisions. Early frosts, major weather events, and lack of water can stunt or stop the development of a plant, enough so to consider a compassionate sacrifice for the sake of another’s growth.
It can be rough out there for plants.
It’s a perfectly rational choice: nature takes over, and microbial recyclers disassemble those discards into available nutrients for future generations
Often, for simplicity, these are relegated to compost. It’s a perfectly rational choice: nature takes over, and microbial recyclers disassemble those discards into available nutrients for future generations.
Of course, many folks also employ “chop and drop” techniques, both in-season and during times of transition.
But what about when you need damage control or get whole plants out of the way and start fresh in their spots? Preparation, a positive attitude, and creativity can get you pretty far, even when the unexpected happens.
Sometimes, we must sacrifice a perfectly example, pollen-bearing plants where seedless production is a goal or cross-pollination among varieties is undesirable. Annuals and biennials in their second year (e.g., wintered kale and other cruciferous veggies) often great candidates for the table or for ing food for other plants in the form of fermented plant juice (FPJ).
When plants have to be cut down for other matters (e.g. a stealthy grow is about to be discovered, site maintenance or development requires access to the space), they may be “saved” by attempting to root cuttings
Storm’s a-brewin’!
Got a hunch (or meteorological tech-enabled prediction) that a major weather event is on its way to wreak destruction on your grow?
Immature fruits and veggies lying scattered on the ground after a high wind or intense rain are only sometimes salvageable. It is better to grab them off the vine before they get battered and try ethylene-assisted paper bag ripening, homebrewing them into vinegar, or making fermented fruit juice (FFJ) to feed your garden.
Companion animal hijinks, garden-adjacent horseplay, the occasional trip-and-fall, and similar mishaps can lead to botanical injuries. Wind-broken and torn, damaged at the roots by washout or flooding, even a rather weather-thrashed plant might not be beyond rescue.
Those hurt while still immature can sometimes recover if their immune systems are well-developed and damaged sites are given some First Aid. You can stake or string up a plant with weakened footing (imagine you’re providing a crutch or a sling). You can make a splint with nearby vines and sticks or use tape for bent and fractured branches. It’s risky to leave plants open


1. Can it be food or medicine?
The first question is whether or not your salad bowl, soup pot, or fermentation vessel has a place for these discards. Mulching-in-place is less work, but with a couple of seasons’ familiarity with your growing environment, you’ll likely identify some recurring space invaders as nutrient-rich, tasty, and often medicinally valuable herbs. Until you need the room for intentional plantings, these precursors feed and support the microbial life in your soil.
The yearly battling back of stinging nettles and aggressively spreading mints is an excellent opportunity to replenish next winter’s tea supply. Lambsquarters and sorrel, frequent opportunists in healthy gardens, can either be chopped at soil level or uprooted by the fistful, roots cut off with shears over a bucket fated to microbe-rich compost tea, reserving the tops for a bright addition to spring salads.
2. Can it be propagated?
Berry bushes, fruit and nut trees, and other multipurpose perennials (e.g., roses, hostas, herbs) are worth the effort to propagate at regular intervals. This practice prepares you, with both supplies and skills, to act when circumstances insist you must. If you end up with more than you can use, rooted cuttings make excellent gifts to welcome new neighbours, thank helpful friends, or brighten communal spaces. They’re also a good way to make a few extra dollars, especially if your collection includes less common varieties. To close the loop, consider putting that income into a “rainy day fund” for supplies to repair and replace future casualties or use it as a fundraiser to upgrade weather-proofing.
The yearly battling back of stinging nettles and aggressively spreading mints is an excellent opportunity to replenish next winter’s tea supply

Perhaps surprisingly, the leaves of some plants harvested for their mature fruits, seeds, roots, or flowers are often edible. These include roses, blueberries, cucumbers and other cucurbits.
Be sure the plants are correctly identified and safe, in the given quantity and stage of maturity, for the particular consuming species (human or non).
This habit is also a good management strategy for building resilience. When a favourite berry bush gets completely shredded by a rambunctious canine (of course, your dog friend would never do this,) hopefully, there are either a couple of rooted copies in pots nearby or thriving in a nearby plot.
If it has at least three nodes, you can stick an otherwise healthy branch, broken or pruned from a plant, into the soil and bury it above the first node. This site, where the plant would have intended to grow more aerial parts, can sprout a new set of roots instead. Lateral, younger growth that hasn’t become woody is most likely to succeed: depending on the time of injury, you might take a handful of cuttings from a limb already in flower. It’s a low-stakes opportunity to see if any will gain a footing because failures will follow the same destiny set when they become detached from the main plant in the first place.

Although often relatively small, each is the same age as its parent and will try to bear at least a little bud after rooting. Clipping these at harvest time will be as easy as picking wildflowers. Under indoor lighting, put them on a shelf or hanging planters to provide better access to light. No patience for 1-2 gram runts? If you have the means, you can try reverting these cuttings to veg and making them into “monster” clones. Otherwise, you may know someone with pollen who could be persuaded to share! Instead of putting these cuttings into an open garden plot or grow room, grab a small pot that can easily be isolated and maintained to maturity in a protected environment. Keep it alive for a minimum of four to six weeks after pollinating, and you might come out with a handful of unique seeds to start your next crop. Remember to pay your pollen-providing friend back in kind!
Strike a balance between allowing beneficials to thrive and not completely excluding or eliminating exposure to challenges
companions that may be transplanted on a whim.
Good candidates include scallions and other onions, celery, salad turnips, lettuce, or anything else you can regrow from the cut end of a harvested homegrown, farmer’s market, or storebought veggie. These are particularly suited to “seat filling” (your garden, like a televised awards show, shall show no empty spots!) because they don’t need to be fully mature to be enjoyed again. It’s also a convenient and cost-reducing diversion of scraps that, while handy for soup stock or compost-making, can be given a second life in your garden. The additional harvest is a 50% reduction in their cost the first time around!
3. Can I “Yes, and…” in this situation?
As a land steward, improvisation comes with the territory. There will be, from time to time, a little unexpected extra room in a garden bed, row, or container. Keep a go-to list of fast-growing
The best-laid plans will inevitably, occasionally, go awry. You can’t protect your garden from all possible environmental surprises and haphazard events, and it’s healthy to practice accepting vagaries that are part of life as a grower. Set out with good intentions, learn new skills, and discover a taste for the unusual! 3
Xavi Kief is a writer, researcher, and lifelong learner with their hands in the dirt and their imagination traversing the universe. Seeking always to deepen and integrate their connection with the living planet and its diverse inhabitants, Xavi finds joy by infusing their practical and playful approach to cultivation with a healthy dose of science.They grow food and medicine for their family and community on their NorthEast Coast homestead.

Organoponics, or organoponicos, is a method of growing developed in Cuba as a response to a massive food shortage caused by the collapse of the Soviet Union in 1989.The traditional way uses low-level concrete walls filled with soil and organic material. Growers laid out drip irrigation lines left over from Soviet-era hydroponic growing practices to deliver water to the crops in the beds. I’m unsure if I can call how I farm ‘Organoponic,’ but it’s pretty close. Let’s go with Organoponics 2.0, Hyrdoganic, Organohydro, or possibly HydroOrganic. All I know is it has changed the way I grow.
All I know is it has changed the way I grow
The Shift
Throughout my horticulture career, I’ve grown hydroponically or organically in soil or LSO beds. In 2021, after a change in ownership of a producer where I was Master Grower, I was tasked with changing how we grew plants. The facility used hydroponic flood and drain tables and dripto-waste irrigation. The new ownership wanted a more organic approach to the cultivation practices.
Many consumers know the difference between hydroponically or organically grown food - in taste, smell, and structure. It got me thinking about producing a product that would appeal to both sides of the spectrum. Because I had been growing hydroponically for several years, I didn’t want to do a complete organic conversion to the facility. It would have been incredibly time-consuming and expensive. So, I used that conversation about hydroponic vs. organic farming to in -

spire a different way to grow our crops. I began introducing water-soluble nutrients (salts) to an organic media with an amended coco coir and peat moss base - the results were surprising and exciting.
Throughout my horticulture career, I’ve grown hydroponically or organically in soil or LSO beds
To begin, I used equal parts peat and coco coir with added perlite (ProMix HP CC came out shortly after, and we began using that) and amended with a base 4-4-4 fertiliser, worm castings, crab meal, bone meal, blood meal, rock phosphate, dolomite lime, azomite, and humic acid. We put the mixed media into two-gallon pots and placed them on flood and drain tables for wick irrigation - with the plan of doing one top watering a week while the plants were wicking up their feed (drip irrigation works well in this media, too). With an ideal balance of porosity and drainage capacity, the media offered a more delicate control over the rhizosphere. It was also more forgiving than soil if mistakes happened during irrigation using nutrients. A few times, new staff members who were learning about irrigation gave the plants too much water, and we found it challenging to overwater with this
media. If someone made a mistake in the nutrient dosage, we could correct it with a ‘mini flush.’ Water retention improved using peat mixed in with coco coir, and usage dropped significantly compared to the previous hydroponic system, which only used a coco coir/ perlite combination.
We also discovered a significantly wider pH range(5.87.2), offering flexibility to play with what and how we were feeding the plants and how they would handle uptake. I would often ‘ebb and flow’ my pH and deliver a lower pH feed one week while giving a higher one the next. I let the plants tell me what, if anything, they were missing. The plants thrived in this range. During the crop cycle and pre-harvest, it was easy to leach any built-up salts out of the media and use it again. We could use the same media three times before adding amendments. Throughout the crop cycle, we found the environments of our grow rooms to be more stable than the hydroponic room, with less stress on the HVAC equipment. The media was excellent for more complex environmental conditions outdoors or in greenhouses.



With an ideal balance of porosity and drainage capacity, the media offered a more delicate control over the rhizosphere
The resulting product was gorgeous, with an increased yield and potency, and the terpene profile was incredibly robust. It appealed to hydroponic and organic consumers and surprised many. In 2022, the company won Canadian Craft Producer of the Year at the GrowUp Conference and Awards.
The feedback has been so positive I haven’t changed how I farm since for the following reasons:
• More control over the root zone
• Better quality, potency, and a more robust end product
• Higher yields
For the water-soluble nutrients, I went with REMO Nutrients. As a long-time customer, I knew their products use high-quality chelated ingredients without chlorides or carbonates. The whole idea was to fill any nutritional gaps that may be in the media we created. We did not follow the feeding chart provided by REMO because of the amendments used.
Just like the pH, I would ‘ebb and flow’’ my total dissolved solids in my nutrient mix - ranging from an EC of 2.7 down to 0.5 through a week of three feedings. I did this until the plants’ final week or two before harvest when the EC was at 0.0.
• More forgiving than soil and easier to correct deficiencies and mistakes
• Better water retention than coco coir
• Better balance of porosity and drainage
• Well suited for challenging environments and easier in indoor environments
• Having water soluble fertilisers fills in any missing gaps there may be in the organic
• material used.
Using the best of both worlds brings the plants to their full potential. I’m sure I’m not the only one who grows this way, and if you do, please feel free to reach out via my social media accounts and let me know your take on it. 3
BIO
With 30 years of cultivation experience, Dustan has dedicated a good portion of his life to medicinal plants. He was a founding partner and Head of Cultivation/Master Grower for Parkland Flower Inc. He is now the Head of Cultivation and Master Grower for Big League Cultivation in Alberta, Canada. He provides incredible genetics to Canadian producers and selected flower and concentrates for the international market.
Becoming an organic-regenerative gardener is worth every effort, helping you produce healthier crops and connect to Nature. The good news is that implementing sustainable practices in your garden can be as simple or complicated as you’d like; many different projects and efforts contribute meaningfully to the health of your plants and surrounding ecosystems. Looking for ideas? Try these 5 Cool Ways to Create an Eco-Friendly & Sustainable Garden Space.
One of the most powerful things you can do as a gardener is to treat your dirt like gold. Living soil will help you grow productive gardens while protecting a precious resource. Forget chemical products; compost is your best friend. You can create a composting system that works for you, regardless of your space. Adding organic matter to your garden instantly boosts soil nutrient content, creates air pockets, and helps the earth better retain moisture. Leave no patch of soil uncovered; always mulch your garden space. Covering the earth with a layer of wood chips or leaf mould will prevent water evaporation and add nutrients to the soil as it decomposes. Consider sheet mulching (lasagna gardening) and hugelkultur beds to build nutrient-rich earth while saving water. And avoid digging if you can. Leaving life below the garden surface intact while nourishing it is a top priority.
Stepanie Rose’s The Regenerative Garden: 80 Practical Projects for Creating a Self-Sustaining Garden Ecosystem is an excellent resource for gardeners leading the change.



We do so much to keep certain critters out of our gardens; don’t forget to put the welcome sign on the gate for many others. Supporting wildlife and making safe spaces for them is essential to thriving ecosystems, and it can be a lot of fun, too. Build some insect hotels or leave stumps or pieces of driftwood in the garden for beneficial bugs to move into so they can help you with pest control. Strategically place birdhouses, baths, or feeders and plant berry bushes to encourage our feathered friends to pop by. Design pollinator islands that include a wide variety of mostly native and only chemical-free plants. Between bee balm and liatris for the bees, coneflowers and milkweed for the butterflies, and foxglove and honeysuckle for the hummingbirds, you’ll end up with a downright gorgeous flower buffet to please the essential pollinators that help your garden grow.
We often hear that we need to go back to our roots, and the saying is true for many different reasons. In The Climate Change Garden: Down to Earth Advice for Growing a Resilient Garden, Sally Morgan and Kim Stoddart write about how gardens of the past were rarely decorative and served the functional purpose of growing food for the family. Weeds were encouraged to grow alongside crops for their medicinal properties and ability to attract pollinators and beneficial insects to the garden. Plus, keeping every inch of ground covered was essential for retaining moisture in the summer, nutrients in the winter, and preventing soil erosion. Take a page from the past; let plants like chickweed, lamb’s quarters and ox-tongue self-seed and grow alongside other plants. They’re beautiful in their own right and create the cottage garden look everyone longs for these days. Fighting Mother Nature is too much work; let her do her thing and reap all the benefits.




Wicking beds are an exciting option for water-conscious gardeners.These large, DIY container-like gardens capture water runoff and store it in a reservoir under the bed’s soil so it’s readily available for the plant roots whenever needed.
Kiss the garden hose goodbye and say hello to healthy crops with strong roots! You can build wicking beds in the ground or as a raised garden, preferably with recycled materials or cedar posts. You’ll need an impermeable barrier at the bottom to act as the reservoir, drainage pipes for water flow, and gravel to store the water. Place garden fabric on the gravel and fill the bed with soil and plants. You can water the wicking bed manually (about once a week in the summer) or connect downspouts to the garden and let the rain do the job for you.
The Regenerative Garden (Rose) offers excellent step-by-step guides to building wicking beds, keyhole gardens, herb spirals, and more.
Finding creative ways to use things you already have in the garden is budgetfriendly and reduces the amount of waste in landfills (or sitting in your shed). In their book, The Urban Garden: 101 Ways to Grow Food and Beauty in the City, Kathy Jentz and Teri Speight encourage gardeners to find new purposes for items rather than buying new ones. Doing so adds layers of history and depth to the garden because it connects you to previous gardeners and owners or past experiences. Anything that holds soil can be a planter if you create drainage holes. Old bathtubs, sinks, rain boots, and metal trucks can all be used as containers. An old brass bed frame makes a garden trellis and metal chairs can be placed anywhere to create a cosy relaxation and garden observation spot. Grow vertically in repurposed rain gutters and edge garden beds with rocks from your travels, old cinder blocks or terracotta roof tiles. Finally, Jentz and Speight warn never to throw out broken garden tools. Have a bucket handy to collect broken parts; you can eventually put something together with the pieces. Besides, old rake heads make great hanging racks for garden gloves and small tools! 3







